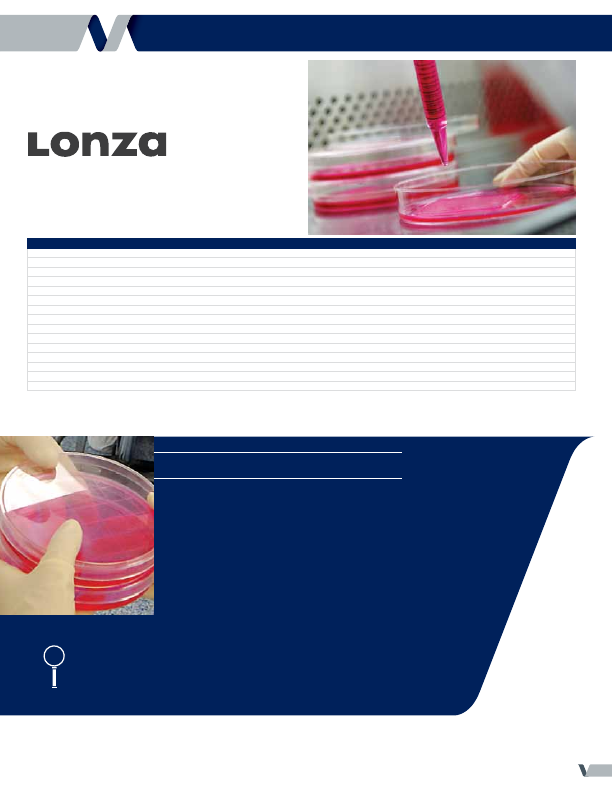
background image

|

|
VWR The Essentials of Tissue Culture 2012 (CAN) |

of Tissue Culture
EssEntials
Th
e
Over 200 PrOducts
to Meet your Tissue
Culture Needs
IdenTIfyIng and CorreCTIng Common Cell growTh Problems
page 8
| guIde To small Volume
Cell CulTure sCale-uP
page 27
| Cell CulTure ConTamInaTIon Through myCoPlasma
page 40

Contents
Media Preparation & Filtration
Classical Media
.. . . . . . . . . . . . . . . . . . . . . . . . . . . . . . . . . . . . . . . . . . . . . . . . . . . . . . . . . . . . . . . . . . . . . . . . . . . . . . . . . . . . . . . . . . . . . . . . . . . . . . . . . . . . . . . . . . . . . . . . . . . . . . . . .
3
Specialty Media
.. . . . . . . . . . . . . . . . . . . . . . . . . . . . . . . . . . . . . . . . . . . . . . . . . . . . . . . . . . . . . . . . . . . . . . . . . . . . . . . . . . . . . . . . . . . . . . . . . . . . . . . . . . . . . . . . . . . . . . . . . . . . . . . .
4
Sera
. . . . . . . . . . . . . . . . . . . . . . . . . . . . . . . . . . . . . . . . . . . . . . . . . . . . . . . . . . . . . . . . . . . . . . . . . . . . . . . . . . . . . . . . . . . . . . . . . . . . . . . . . . . . . . . . . . . . . . . . . . . . . . . . . . . . . . . . . . . . . . . . . . . . . . . . . .
4
-
5
Antibodies
.. . . . . . . . . . . . . . . . . . . . . . . . . . . . . . . . . . . . . . . . . . . . . . . . . . . . . . . . . . . . . . . . . . . . . . . . . . . . . . . . . . . . . . . . . . . . . . . . . . . . . . . . . . . . . . . . . . . . . . . . . . . . . . . . . . . . . . . . . . . . . .
5
Buffers, Buffered Salines, Reagents
.. . . . . . . . . . . . . . . . . . . . . . . . . . . . . . . . . . . . . . . . . . . . . . . . . . . . . . . . . . . . . . . . . . . .
6
-
7
Antibiotics
.. . . . . . . . . . . . . . . . . . . . . . . . . . . . . . . . . . . . . . . . . . . . . . . . . . . . . . . . . . . . . . . . . . . . . . . . . . . . . . . . . . . . . . . . . . . . . . . . . . . . . . . . . . . . . . . . . . . . . . . . . . . . . . . . . . . . . . . . . . . . . .
7
Growth Factors: Identifying and
Correcting Common Cell Growth Problems
.. . . . . . . . . . . . . . . . . . . . . . . . . . . . . . . . . . . . . . . . . . . . . . . .
7
-
8
Media Selection
.. . . . . . . . . . . . . . . . . . . . . . . . . . . . . . . . . . . . . . . . . . . . . . . . . . . . . . . . . . . . . . . . . . . . . . . . . . . . . . . . . . . . . . . . . . . . . . . . . . . . . . . . . . . . . . . . . . . . . . . . . . . . . . .
9
Filtration
.. . . . . . . . . . . . . . . . . . . . . . . . . . . . . . . . . . . . . . . . . . . . . . . . . . . . . . . . . . . . . . . . . . . . . . . . . . . . . . . . . . . . . . . . . . . . . . . . . . . . . . . . . . . . . . . . . . . . . . . . . . . . . . . . . . . . . .
10
-
13
Cell Cultivation
General Flasks, Plates, Dishes
.. . . . . . . . . . . . . . . . . . . . . . . . . . . . . . . . . . . . . . . . . . . . . . . . . . . . . . . . . . . . . . . . . . . . . . . . . . . . .
14
-
18
Improved Surfaces for Different
Cell Culture Applications
.. . . . . . . . . . . . . . . . . . . . . . . . . . . . . . . . . . . . . . . . . . . . . . . . . . . . . . . . . . . . . . . . . . . . . . . . . . . . . . . . . . . . . . . . . . . . . . . . . . . .
16
Specialty Surface Flasks, Plates, Dishes
.. . . . . . . . . . . . . . . . . . . . . . . . . . . . . . . . . . . . . . . . . . . . . . . . . . . .
19
-
22
Membrane Inserts
.. . . . . . . . . . . . . . . . . . . . . . . . . . . . . . . . . . . . . . . . . . . . . . . . . . . . . . . . . . . . . . . . . . . . . . . . . . . . . . . . . . . . . . . . . . . . . . . . . . . . . . . . . . . .
23
-
24
Roller Bottles
.. . . . . . . . . . . . . . . . . . . . . . . . . . . . . . . . . . . . . . . . . . . . . . . . . . . . . . . . . . . . . . . . . . . . . . . . . . . . . . . . . . . . . . . . . . . . . . . . . . . . . . . . . . . . . . . . . . . . . . . . . .
24
-
25
Chambers & Systems
.. . . . . . . . . . . . . . . . . . . . . . . . . . . . . . . . . . . . . . . . . . . . . . . . . . . . . . . . . . . . . . . . . . . . . . . . . . . . . . . . . . . . . . . . . . . . . . . . . . . .
25
-
27
Growing More Cells: A Simple Guide
to Small Volume Cell Culture Scale-Up
.. . . . . . . . . . . . . . . . . . . . . . . . . . . . . . . . . . . . . . . . . . . . . . . . . . . . . . . . . . . . . . .
26
Pipetting
.. . . . . . . . . . . . . . . . . . . . . . . . . . . . . . . . . . . . . . . . . . . . . . . . . . . . . . . . . . . . . . . . . . . . . . . . . . . . . . . . . . . . . . . . . . . . . . . . . . . . . . . . . . . . . . . . . . . . . . . . . . . . . . . . . . . . . .
27
-
30
Shakers
.. . . . . . . . . . . . . . . . . . . . . . . . . . . . . . . . . . . . . . . . . . . . . . . . . . . . . . . . . . . . . . . . . . . . . . . . . . . . . . . . . . . . . . . . . . . . . . . . . . . . . . . . . . . . . . . . . . . . . . . . . . . . . . . . . . . . . . . . . . . . . . . . . .
31
Incubators
.. . . . . . . . . . . . . . . . . . . . . . . . . . . . . . . . . . . . . . . . . . . . . . . . . . . . . . . . . . . . . . . . . . . . . . . . . . . . . . . . . . . . . . . . . . . . . . . . . . . . . . . . . . . . . . . . . . . . . . . . . . . . . . . . .
31
-
33
Biosafety Cabinets
.. . . . . . . . . . . . . . . . . . . . . . . . . . . . . . . . . . . . . . . . . . . . . . . . . . . . . . . . . . . . . . . . . . . . . . . . . . . . . . . . . . . . . . . . . . . . . . . . . . . . . . . . . . .
33
-
35
Enclosures and Biosafety Cabinets
.. . . . . . . . . . . . . . . . . . . . . . . . . . . . . . . . . . . . . . . . . . . . . . . . . . . . . . . . . . . . . . . . . . . . . . . . . . .
34
Maintaining Cabinet Functionality
.. . . . . . . . . . . . . . . . . . . . . . . . . . . . . . . . . . . . . . . . . . . . . . . . . . . . . . . . . . . . . . . . . . . . . . . . . . .
34
Cell Counting
Cell Counting
.. . . . . . . . . . . . . . . . . . . . . . . . . . . . . . . . . . . . . . . . . . . . . . . . . . . . . . . . . . . . . . . . . . . . . . . . . . . . . . . . . . . . . . . . . . . . . . . . . . . . . . . . . . . . . . . . . . . . . . . .
35
-
36
Cell Harvesting & Disruption
Mycoplasma Detection
.. . . . . . . . . . . . . . . . . . . . . . . . . . . . . . . . . . . . . . . . . . . . . . . . . . . . . . . . . . . . . . . . . . . . . . . . . . . . . . . . . . . . . . . . . . . . . . . . . . . . . . . .
37
Cell Culture Contamination Through Mycoplasma
.. . . . . . . . . . . . . . . . . . . . . . . . . . . . . . . .
37
Cell Dissociation
.. . . . . . . . . . . . . . . . . . . . . . . . . . . . . . . . . . . . . . . . . . . . . . . . . . . . . . . . . . . . . . . . . . . . . . . . . . . . . . . . . . . . . . . . . . . . . . . . . . . . . . . . . . . . . . . . . . . . . . . . . .
38
Vortex Mixers
. . . . . . . . . . . . . . . . . . . . . . . . . . . . . . . . . . . . . . . . . . . . . . . . . . . . . . . . . . . . . . . . . . . . . . . . . . . . . . . . . . . . . . . . . . . . . . . . . . . . . . . . . . . . . . . . . . . . . . . . . . . . . . . . . .
39
Centrifuges
.. . . . . . . . . . . . . . . . . . . . . . . . . . . . . . . . . . . . . . . . . . . . . . . . . . . . . . . . . . . . . . . . . . . . . . . . . . . . . . . . . . . . . . . . . . . . . . . . . . . . . . . . . . . . . . . . . . . . . . . . . . . . . .
40
-
41
Transfection
.. . . . . . . . . . . . . . . . . . . . . . . . . . . . . . . . . . . . . . . . . . . . . . . . . . . . . . . . . . . . . . . . . . . . . . . . . . . . . . . . . . . . . . . . . . . . . . . . . . . . . . . . . . . . . . . . . . . . . . . . . . . . .
42
-
43
Cryopreservation
Cryovials
.. . . . . . . . . . . . . . . . . . . . . . . . . . . . . . . . . . . . . . . . . . . . . . . . . . . . . . . . . . . . . . . . . . . . . . . . . . . . . . . . . . . . . . . . . . . . . . . . . . . . . . . . . . . . . . . . . . . . . . . . . . . . . . . . . . . . . .
44
-
46
Labels & Storage
.. . . . . . . . . . . . . . . . . . . . . . . . . . . . . . . . . . . . . . . . . . . . . . . . . . . . . . . . . . . . . . . . . . . . . . . . . . . . . . . . . . . . . . . . . . . . . . . . . . . . . . . . . . . . . . . .
46
-
48
Aspects of Cryopreservation
.. . . . . . . . . . . . . . . . . . . . . . . . . . . . . . . . . . . . . . . . . . . . . . . . . . . . . . . . . . . . . . . . . . . . . . . . . . . . . . . . . . . . . . . . . . .
47
Cryoreagents
.. . . . . . . . . . . . . . . . . . . . . . . . . . . . . . . . . . . . . . . . . . . . . . . . . . . . . . . . . . . . . . . . . . . . . . . . . . . . . . . . . . . . . . . . . . . . . . . . . . . . . . . . . . . . . . . . . . . . . . . . . . . . . . . . . .
48
Liquid Nitrogen
. . . . . . . . . . . . . . . . . . . . . . . . . . . . . . . . . . . . . . . . . . . . . . . . . . . . . . . . . . . . . . . . . . . . . . . . . . . . . . . . . . . . . . . . . . . . . . . . . . . . . . . . . . . . . . . . . . . . . . . . . . . . .
49
Freeze Controllers
.. . . . . . . . . . . . . . . . . . . . . . . . . . . . . . . . . . . . . . . . . . . . . . . . . . . . . . . . . . . . . . . . . . . . . . . . . . . . . . . . . . . . . . . . . . . . . . . . . . . . . . . . . . . . . . . . . . . . .
49
Freezers
.. . . . . . . . . . . . . . . . . . . . . . . . . . . . . . . . . . . . . . . . . . . . . . . . . . . . . . . . . . . . . . . . . . . . . . . . . . . . . . . . . . . . . . . . . . . . . . . . . . . . . . . . . . . . . . . . . . . . . . . . . . . . . . . . . . . . . . . . . . . . . . . . .
50
VWR offers a comprehensive product
selection for all cell culture applications.
In this edition of VWR Essentials, we have
included the technical expertise of our top
suppliers to provide useful tips and know-
how to improve and enhance your research
results. Whether you’re a lab assistant in a
university or a Ph.D. researcher in a stem
cell research facility, you’ll want to keep this
guide handy for quick and easy reference.
find Complete Product listings at
vwr.com
or Call
1.800.932.5000
|
2
2
|
The
EssEntials
of
Tissue Culture
find Complete Product listings at
vwr.com
or Call
1.800.932.5000
|
3

BioWhittaker
®
Classic Cell Culture Media, lonza
•
Formulated according to recommendations from the Tissue Culture Association and
manufactured under cGMP regulations
•
Powder media are produced with phenol red and without sodium bicarbonate
•
Liquid media lots are tested for sterility, pH, osmolality, and cell growth promotion
•
If required, products are also tested for endotoxin concentration
Description
Size
Cat. No.
Each
Basal Medium Eagle, Cryoprotective Medium, with 15% DMSO, without L-Glutamine, Use 1:1 with Growth Medium
100mL
CA12001-550
29.57
Dulbecco’s Modified Eagle’s Medium, with 4.5 g/L Glucose and L-Glutamine
500mL
CA12001-566
18.31
Dulbecco’s Modified Eagle’s Medium, with 4.5 g/L Glucose and L-Glutamine
1 L
CA12001-568
26.95
Dulbecco’s Modified Eagle’s Medium, with 4.5 g/L Glucose, without L-Glutamine and Phenol Red
500mL
CA12001-630
30.59
Dulbecco’s Modified Eagle’s Medium, with 4.5 g/L Glucose, without L-Glutamine, Screened to Support Hybridoma Growth
500mL
CA12001-344
26.95
Dulbecco’s Modified Eagle’s Medium, F-12, 1:1 Mixture, with 3.151 g/L Glucose, 15 mM HEPES, and L-Glutamine
500mL
CA12001-600
23.77
Modifed Eagle’s Medium (EMEM), with Earle’s Balanced Salt Solution and L-Glutamine
500mL
CA12001-570
16.94
Modifed Eagle’s Medium (EMEM), with Earle’s Balanced Salt Solution, L-Glutamine, and Non-Essential Amino Acids, without Calcium
450mL
CA12001-514
37.52
Modifed Eagle’s Medium (EMEM), with Earle’s Balanced Salt Solution and 25 mM HEPES, without L-Glutamine
500mL
CA12001-552
26.95
Modifed Eagle’s Medium (EMEM), with Earle’s Balanced Salt Solution, without L-Glutamine and Phenol Red (Virus Plaquing Medium)
100mL
CA12002-016
13.53
Modifed Eagle’s Medium (EMEM), Joklik’s Formulation for Suspension Cultures
1 L
CA12002-002
34.00
NCTC-109 Medium, with Earle’s Balanced Salt Solution and L-Glutamine, Screened to Support Hybridoma Growth
100mL
CA12001-348
39.69
RPMI 1640, with L-Glutamine
500mL
CA12001-590
16.72
RPMI 1643, with 25 mM HEPES and L-Glutamine
500mL
CA12001-534
23.31
RPMI 1647, without L-Glutamine
500mL
CA12001-558
16.60
DETERGENT CAN HELP YouR CELL CuLTuRE VIABILITY
Many serum-free applications involve dynamic (agitated) instead of static (not
agitated) suspension culture. Agitation can cause shearing forces that will
damage a growing cell culture. one way to avoid these shearing forces is to
add a detergent to the culture medium. Detergent molecules are hydrocarbon
chains that contain a polar end (water-loving, hydrophilic), and a non-polar
end (water-repellent, hydrophobic). Also known as surfactants, detergents
decrease the surface tension of water and solubilize compounds that are
poorly soluble in water. Think of the effect of dish washing detergent on
food oils.
Pluronic
®
F68 is a non-ionic detergent used in suspension culture
media to stabilize the cell membrane from shear forces resulting from
agitation. F68 is a non-ionic surfactant that does not denature proteins
as ionic surfactants, such as sodium dodecyl sulfate (SDS), do. For
your convenience, Lonza includes F68 in most serum-free media
intended for dynamic suspension culture. Final concentration of
F68 in serum-free media for this application is typically 1.0 gram/
liter, or 0.1%.
F cus
nformation
find Complete Product listings at
vwr.com
or Call
1.800.932.5000
|
2
Media PreParation & Filtration
Classical media
find Complete Product listings at
vwr.com
or Call
1.800.932.5000
|
3

Fetal Bovine sera, Paa laboratories
•
Sera is tested for viruses and microorganisms and receives additional testing
according to 9CFR and EP regulations
•
GOLD sera is chromatographically purified and fractionated, then the individual
components are recombined in a defined composition, eliminating batch-to-batch
variation
•
GOLD sera also contains no additives from other sera and is characterized by a very
low content of IgG antibodies
•
ES cell-tested serum supports the growth of undifferentiated ES cells and has
low nonspecific stimulation; ideal for morphology studies in stem cells, as well as
phosphatase marker expression
•
Heat inactivated serum has been heated to inactivate the complement system,
antibodies, and other active enzymes
•
All sera are sterile, filtered, and packaged in unbreakable, gamma-irradiated PET
bottles
•
Production facilities comply with cGMP guidelines and are registered with the FDA
and EDQM
•
Size
..
500mL (16oz.)
Origin
Cat. No.
Each
Fetal Bovine Serum, Standard Quality
Canada
CAA15-701
177.57
USDA Approved
CA95025-538
148.63
Fetal Bovine Serum, GOLD
Canada
CA95042-112
133.33
USA
CA95025-542
174.07
USDA Approved
CA95025-546
171.39
Fetal Bovine Serum, ES Cell-Tested
Various
CA95039-626
298.14
Fetal Bovine Serum, Heat Inactivated
USA
CA95025-550
183.44
insect Cell Culture Media, HiMedia
•
Use specialized insect media for recombinant protein expression, propagation of
insect viruses, or for studies on control of vector bourne diseases
•
Insect culture media offers higher tolerance to osmolality and temperature
fluctuations
•
Expressed proteins are antigenically, immunologically, and functionally similar to
their authentic counterparts
•
Easily culture large quantities of posttranslationally modified eukaryotic proteins
•
High quality materials ensures lot-to-lot consistency
Description
Cat. No.
Each
1 L Bottles
D-22 Insect Medium
CA
95038-644
14.02
Grace’s Insect Medium
CA95037-608
17.34
IPL-41 Insect Medium
CA95038-648
14.02
Mitsuhashi and Maramorosch Insect Medium
CA95037-612
13.25
Schneider’s Insect Medium
CA95037-616
17.34
Shield’s and Sang M3 Insect Medium
CA95038-640
14.02
TC-100 Insect Medium
CA95038-652
17.52
TNM-FH Insect Medium
CA95038-656
19.19
5 L Bottles
D-22 Insect Medium
CA95039-060
69.83
Grace’s Insect Medium
CA95039-036
87.34
IPL-41 Insect Medium
CA95039-066
69.83
Mitsuhashi and Maramorosch Insect Medium
CA95039-042
53.11
Schneider’s Insect Medium
CA95039-048
87.34
Shield’s and Sang M3 Insect Medium
CA95039-054
69.83
TC-100 Insect Medium
CA95039-072
87.34
TNM-FH Insect Medium
CA95039-078
96.05
Culture Media and Media Bases
For Microbiology and Molecular Biology Applications
•
Mueller Hinton broth is used to determine the susceptibility of bacteria to
sulphonamides by the tube dilution method
•
Luria broth is used for the cultivation and maintenance of recombinant strains of
Escherichia coli
•
Nutrient Broth is used for cultivation of less fastidious organisms
•
Lactose broth is used for the detection of coliform bacteria in water, foods, and
dairy products
•
Letheen broth AOAC is used for determination of bacterial activity of quaternary
ammonium compounds using Escherichia coli or Staphylococcus aureus
•
Contact your VWR Life Science Specialist to learn more about the complete range of
HiMedia products available
Description
Cat. No.
Each
Brain Heart Infusion Broth
CA
95021-488
105.76
Brain Heart Infusion Broth, HiVeg
CA61000-752
124.06
Buffered Peptone Water with NaCl
CA95020-848
108.29
Casein Soybean Digest Agar
CA95021-622
70.34
Lactose Broth
CA95020-262
80.26
Letheen Broth, AOAC
CA95022-874
146.84
Luria Broth
CA95022-016
63.05
Luria Bertani Agar, Miller
CA95020-584
89.69
Luria Bertani HiVeg Agar, Miller
CA61000-490
94.25
MacConkey Agar w/ 0.15% Bile Salts, CV, and NaCl
CA95020-204
95.48
Mueller Hinton Agar
CA95039-350
93.97
Mueller Hinton Broth
CA95039-356
121.24
Nutrient Agar
CA95019-996
121.26
Nutrient Broth
CA95019-998
82.21
Nutrient Broth, HiVeg
CA61000-218
102.08
Plate Count Agar
CA95020-238
98.80
Plate Count Agar, HiVeg
CA61000-378
103.68
Potato Dextrose Agar
CA95020-250
117.55
Sabouraud Dextrose Agar, HiVeg
CA61000-326
81.66
Soybean Casein Digest Medium
(Tryptone Soya Broth)
CA95020-030
48.18
Soybean HiVeg Agar
CA61000-848
73.96
find Complete Product listings at
vwr.com
or Call
1.800.932.5000
|
4
4
|
The
EssEntials
of
Tissue Culture
find Complete Product listings at
vwr.com
or Call
1.800.932.5000
|
5
Media PreParation & Filtration
speciality media | sera

cellgro
®
animal sera, Mediatech
•
Premium fetal bovine serum is only collected from herds within the U.S.
•
USDA-approved fetal bovine serum is derived specifically for USDA-certified facilities located
outside of U.S. boundaries
•
Donor calf and horse serum is collected from standing herds located within the U.S.
•
Animals are tested regularly by a veterinarian and certified to be disease-free
•
Chemical constituents within the sera are measured to ensure lot-to-lot consistency
•
Size
..
500mL (16 oz.)
Description
Cat. No.
Each
USDA-Approved Fetal Bovine Serum, Regular
CA45000-734
325.09
USDA-Approved Fetal Bovine Serum, Heat-Inactivated
CA45000-736
381.95
Premium Fetal Bovine Serum, Regular
CA45001-106
467.66
Premium Fetal Bovine Serum, Heat-Inactivated
CA45001-108
475.76
Donor Calf Serum
CA45001-060
81.71
Donor Horse Serum
CA45001-058
81.85
cellgro
®
Human sera, Mediatech
•
Each donor unit of plasma is tested for the presence of Hepatitis B
and C; HIV-1, -1Ag, and -2; and ALT by FDA-approved methods
•
All plasma is collected from within the U.S.
Description
Cat. No.
Each
Human AB Serum
CA45001-062
187.27
Finding a sPeCiFiC antibody
Can be like Finding your
way through a Maze.
Fortunately, VWR can guide you.
Quickly find the specific antibody you need
from Vwr’s broad antibody product portfolio.
Vwr carries primary and secondary antibodies
that can be used with western blotting, elIsas,
immunohistochemistry, immunoprecipitation,
immunofluoresence, neutralization, and flow
cytometry.
at Vwr you’ll find
•
more than 42,000 antibodies
•
an expanding supplier base
•
antibodies from multiple species
•
antibodies with multiple conjugations
•
antibodies for all major applications
Visit
ca.vwr.com
for more information.
find Complete Product listings at
vwr.com
or Call
1.800.932.5000
|
4
find Complete Product listings at
vwr.com
or Call
1.800.932.5000
|
5
Media PreParation & Filtration
sera | antibodies

luminescent Cell-based assays, lonza
•
Detect as few as ten dead eukaryotic cells per well allowing lower seeding densities
and more assays
•
No separate mixing or centrifugation steps
•
Highly reproducible results
•
Samples can be processed and analyzed in <10 minutes in a 96-well plate
•
Also compatible with 284-well plates
BioWhittaker
®
Buffers and Reagents, lonza
•
Manufactured in accordance with cGMP regulations
•
Cell culture tested to assure compatibility
•
All trypsin products are manufactured with irradiated trypsin, tested for porcine parvovirus, and screened for mycoplasma
•
All water products are WFI grade prepared by ultrafiltration, reverse osmosis, deionization, distillation, and sterile filtration
Description
Concentration
Size
Cat. No.
Each
Dulbecco’s Phosphate Buffered Saline
1X, 0.0095 M
500 mL
CA12001-664
14.44
Dulbecco’s Phosphate Buffered Saline
1X, 0.0095 M
1 L
CA12001-666
25.81
Dulbecco’s Phosphate Buffered Saline
10X, 0.0095 M
500 mL
CA12001-672
25.81
Dulbecco’s Phosphate Buffered Saline
10X, 0.0095 M
1 L
CA12001-674
38.55
HEPES Buffer, Contains 238.3 g/L in Normal Saline
1 M
100 mL
CA12001-708
50.37
HEPES Buffer, Contains 238.3 g/L in Normal Saline
1 M
500 mL
CA12001-710
256.99
L-Glutamine, Supplied at 29.3 mg/mL in 0.85% Saline
200 mM
100 mL
CA12001-698
20.47
Phosphate Buffered Saline
1X, 0.0067 M
500 mL
CA12001-676
15.81
Phosphate Buffered Saline
1X, 0.0067 M
1 L
CA12001-678
21.61
Phosphate Buffered Saline
10X, 0.0067 M
1 L
CA12001-680
21.72
Trypan Blue, 0.4% Prepared in 0.85% Saline
—
100 mL
CA12002-038
15.69
Trypsin-Versene (EDTA) Mixture, Contains 0.5 g/L Trypsin 1:250 and 0.2 g/L Versene (EDTA)
1X
100 mL
CA12001-660
8.76
Versene (EDTA), 0.2 g/L Ethylenediaminetetraacetic Acid (0.53 mM) in DPBS
0.02%
100 mL
CA12001-704
10.92
Water for Cell Culture
—
500 mL
CA12001-356
11.37
Water for Cell Culture
—
1 L
CA12001-706
15.81
Water for Cell Culture
—
20 L
CA11006-294
202.80
toxilight
®
non-Destructive Cytotoxicity Bioassay Kit
•
Cytolysis assay kit designed to measure the release of adenylate kinase (AK)
•
Allows for kinetic analysis of cell death to be performed on the original cells
•
Gives earlier indication of leaky membrane than LDH assays
Vialight
®
Cell Proliferation &
Cytotoxicity Bioassay Kit
•
Incorporates bio-luminescent detection of cellular ATP as a measure of viability
•
Most accurate, effective, and direct way to measure the number of living cells
in a culture
Description
No. of Tests
Cat. No.
Price
ToxiLight Kit
500
CA89125-774
250.80
ToxiLight Kit
1,000
CA89125-776
444.00
ViaLight Plus Kit
500
CA89125-756
228.00
ViaLight Plus Kit
1,000
CA89125-758
409.20
ViaLight Plus Kit
10,000
CA89125-760
2990.40
Proliferation and Cytotoxicity Kit ViaLight MDA Plus, Microbial
1,000
CA89125-770
442.80
Proliferation and Cytotoxicity Kit ViaLight MDA Plus, Microbial
10,000
CA89125-772
3070.80
The ToxiLight BioAssay kit exploits the fact that AK is released from cells when they
die, removing the need for cell lysis. Repeated samples of supernatant can therefore
be taken over time without disrupting the cells themselves.
F cus
nformation
find Complete Product listings at
vwr.com
or Call
1.800.932.5000
|
6
6
|
The
EssEntials
of
Tissue Culture
find Complete Product listings at
vwr.com
or Call
1.800.932.5000
|
7
Media PreParation & Filtration
buffers, buffered salines, reagents

BioWhittaker
®
Buffers and Reagents, lonza
•
Manufactured in accordance with cGMP regulations
•
Cell culture tested to assure compatibility
•
All trypsin products are manufactured with irradiated trypsin, tested for porcine parvovirus, and screened for mycoplasma
•
All water products are WFI grade prepared by ultrafiltration, reverse osmosis, deionization, distillation, and sterile filtration
Description
Concentration
Size
Cat. No.
Each
Dulbecco’s Phosphate Buffered Saline
1X, 0.0095 M
500 mL
CA12001-664
14.44
Dulbecco’s Phosphate Buffered Saline
1X, 0.0095 M
1 L
CA12001-666
25.81
Dulbecco’s Phosphate Buffered Saline
10X, 0.0095 M
500 mL
CA12001-672
25.81
Dulbecco’s Phosphate Buffered Saline
10X, 0.0095 M
1 L
CA12001-674
38.55
HEPES Buffer, Contains 238.3 g/L in Normal Saline
1 M
100 mL
CA12001-708
50.37
HEPES Buffer, Contains 238.3 g/L in Normal Saline
1 M
500 mL
CA12001-710
256.99
L-Glutamine, Supplied at 29.3 mg/mL in 0.85% Saline
200 mM
100 mL
CA12001-698
20.47
Phosphate Buffered Saline
1X, 0.0067 M
500 mL
CA12001-676
15.81
Phosphate Buffered Saline
1X, 0.0067 M
1 L
CA12001-678
21.61
Phosphate Buffered Saline
10X, 0.0067 M
1 L
CA12001-680
21.72
Trypan Blue, 0.4% Prepared in 0.85% Saline
—
100 mL
CA12002-038
15.69
Trypsin-Versene (EDTA) Mixture, Contains 0.5 g/L Trypsin 1:250 and 0.2 g/L Versene (EDTA)
1X
100 mL
CA12001-660
8.76
Versene (EDTA), 0.2 g/L Ethylenediaminetetraacetic Acid (0.53 mM) in DPBS
0.02%
100 mL
CA12001-704
10.92
Water for Cell Culture
—
500 mL
CA12001-356
11.37
Water for Cell Culture
—
1 L
CA12001-706
15.81
Water for Cell Culture
—
20 L
CA11006-294
202.80
identifying and Correcting
Common Cell growth
Problems
John a. ryan, Ph.d., Corning Incorporated
The following is an excerpt from the more detailed document of
the same name found on the vwr.com literature page.
Introduction
Although very popular among life science researchers,
cell culture can be a very difficult tool to work with in
the laboratory. Unlike other common laboratory tools
such as electrophoresis or chromatography, cell culture
makes dynamic, ongoing use of living organisms. These
living cultures often respond to our mistakes not only by
the erratic behavior common to other laboratory tools,
but by dying - the total, irreplaceable destruction of the
tool itself.
Because of the complex nature of cell culture, identifying
the underlying causes of culture behavior problems is
often a difficult, time-consuming task. Erratic culture
behavior can take many forms; unusual growth patterns
or inconsistent, spotty, and uneven cell attachment are
the most common problems. Gradual or abrupt changes
in growth rate or unexplainable experimental results are
also experienced occasionally. In cell culture, any sudden
change is suspect and a potential problem and, there-
fore, to be avoided.
Surface Treatment Process
The initial and most common suspects for cell culture
problems are usually either the culture vessels or the
medium being used. Much of the suspicion surrounding
plastic cell culture vessels is due to the mystery or lack
of understanding concerning the special treatment
process used to modify the surface of the plastic. Virgin
polystyrene, the resin used to manufacture most cell
culture vessels, is hydrophobic in its untreated state.
Protein attachment factors do not bind well to this
natural surface resulting in poor cell adhesion and
growth. Because of this, either a corona discharge or
plasma treatment is used under carefully controlled
conditions during the manufacturing process to insert
oxygen atoms (in the form of carboxyl groups) into
the backbone of the polystyrene chain (Ramsey et al,
1984; Amstein and Hartman,1975; Hudis, 1974). This
alteration of the plastic polymer (not a peelable coating)
results in a hydrophilic surface with a net negative
charge that creates a surface suitable for cell attachment
and growth. The culture vessels are then sterilized and
thoroughly evaluated by quality control tests to insure
they received the proper degree of treatment.
Since this modified surface is not visibly different from
the untreated surface, there is no easy way, short of
growing cells, for customers to check the adequacy
of the treatment process. As a result, many customers
assume cell attachment and growth problems are caused
by mistakes made during manufacturing. It is very
continued on next page
antibiotics and antimycotics, lonza
Description
Size
Cat. No.
Each
Amphotericin B
250 µg/mL
20 mL
CA12002-034
25.81
250 µg/mL
100 mL
CA12002-032
77.21
Gentamicin Sulfate
10 mg/mL; Screw Cap Vial
10 mL
CA12001-688
12.28
10 mg/mL; Screw Cap Vial
10 x 10 mL
CA12001-686 121.67
50 mg/mL; Crimp Top Vial
10 mL
CA12001-690
42.87
50 mg/mL; Screw Cap Vial
10 mL
CA12001-684
41.85
50 mg/mL; Screw Cap Vial
10 x 10 mL
CA12001-682 333.18
Penicillin-Streptomycin Mixtures
Contains 5000 Units Potassium Penicillin and 5000 µg Streptomycin
Sulfate per mL in 0.85% Saline
100 mL
CA12001-350
15.81
Contains 10,000 Units Potassium Penicillin and 10,000 µg
Streptomycin Sulfate per mL in 0.85% Saline
100 mL
CA12001-692
16.94
Contains 10,000 Units Potassium Penicillin and 10,000 µg
Streptomycin Sulfate per mL in 0.85% Saline
500 mL
CA12001-694
81.87
Contains 25 µg Fungizone, 10,000 Units Potassium Penicillin, and
10,000 µg Streptomycin Sulfate per mL in 0.85% Saline
20 mL
CA12001-714
15.58
Contains 25 µg Fungizone, 10,000 Units Potassium Penicillin, and
10,000 µg Streptomycin Sulfate per mL in 0.85% Saline
100 mL
CA12001-712
28.31
Contains 20,000 Units Potassium Penicillin and 20,000 µg
Streptomycin Sulfate per mL in 0.85% Saline
500 mL
CA12001-324
51.06
Contains 25,000 Units Potassium Penicillin and 25,000 µg
Streptomycin Sulfate per mL in 0.85% Saline
25 x 4.5 mL
CA12001-354 231.97
Contains 29.2 mg L-Glutamine, 25,000 Units Potassium Penicillin,
and 25,000 µg Streptomycin Sulfate per mL in 0.85% Saline
25 x 4.5 mL
CA12001-352 196.72
Cell Culture Reagents, BD
™
BD B
i
osc
i
ences
•
For additional sizes, contact your VWR Sales Representative
Description
Size
Cat. No.
Each
BD ITS Premix Universal Culture Supplement
(20 L Equivalent)
20 mL
CACB354350
411.97
BD MITO
™
+ Serum Extender (5 L Equivalent)
5 mL
CACB355006
174.56
BD NuSerum
™
Growth Medium Supplement
500 mL
CACB355500
149.10
BD NuSerum IV Growth Medium Supplement
500 mL
CACB355504
279.73
Bovine Pituitary Extract (BPE)
5 x 15 mg
CACB-356123A
351.08
ECGS, Bovine
15 mg
CACB354006
113.78
ECGS, Bovine
100 mg
CACB356006
360.49
EGF, Human, Recombinant
100 µg
CACB354052
189.35
EGF, Mouse, Natural, Culture Grade
100 µg
CACB354001
166.82
bFGF, Human, Recombinant
10 µg
CACB354060
113.49
IL-2, Human, Recombinant
10,000 Units
CACB354043
206.57
IL-2, Human, Recombinant
50,000 Units
CACB356043
669.38
IL-3, Mouse, Recombinant
10 µg
CACB354058
573.38
IL-3 Cell Culture Supplement, Mouse
25 mL
CACB354040
287.76
IL-4, Human, Recombinant
5 µg
CACB354068
288.56
2.5S NGF, Mouse Natural
1 mg
CACB-356005A
1597.82
7S NGF, Mouse Natural
100 µg
CACB354009
237.74
TGF-ß, Human, Natural
10 µg
CACB-356040A
1628.12
T-STIM
™
(IL-2 Supplement) with ConA, Rat
100 mL
CACB354115
533.07
VEGF, human recombinant
10 µg
CACB354107
639.42
find Complete Product listings at
vwr.com
or Call
1.800.932.5000
|
6
find Complete Product listings at
vwr.com
or Call
1.800.932.5000
|
7
Media PreParation & Filtration
buffers, buffered salines, reagents | antibiotics

continued from previous page
important that the plastic culture vessel’s status as
the suspected cause of the problem be resolved as
quickly as possible so the real cause can be identified
and eliminated. Usually, the first step is comparing the
performance of the suspected vessel against the same
product from a different production lot, or against
similar products from another manufacturer. If a dif-
ference is found or the results are not clear, then it is
time to contact the product manufacturer for assistance.
Once the vessel is eliminated as the problem’s cause,
the customer can then continue to look elsewhere for a
solution. The following examples will help identify some
common problems and causes often incorrectly associ-
ated with poor surface treatment of plastic vessels and,
where possible, will offer some solutions that can be
used to eliminate them.
Problems Related to Technique
The greatest opportunity for cell culture problems occurs
during the day-to-day activities of feeding and main-
taining the cultures. Culture loss due to contamination is
one of the most frequent and more serious of these prob-
lems. However, many other problems, while less serious
and not as noticeable as contamination, still adversely
affect the cultures and experiments. Often, the first sign
that something is wrong occurs when the cells are micro-
scopically examined and uneven or unusual patterns of
cell attachment or growth are observed. Identifying the
problem’s cause is the first and usually most difficult
step. Sometimes transient growth problems occur and
then disappear without ever identifying a cause. Please
note that many of these growth problems are not readily
observed during routine microscopic observation of live
cultures. The occurrence and extent of these problems is
best observed when sample cultures are first fixed (2.5%
gluteraldehyde or 70% ethanol) and stained (1% crystal
violet stain) prior to observation.
Problems Related to Culture Media
Both culture medium and culture vessels are prime
suspects whenever mysterious cell growth or attachment
problems occur without obvious causes. Unless heavily
contaminated, good culture medium is not visibly
different in appearance from defective culture medium.
The only good way to determine medium quality is to
attempt to grow cells with it; this is the basic quality
control procedure used by most media manufacturers
and the only good method for homemade media as well.
Cell cultures respond to deficient or toxic media in
different ways depending upon both the nature and the
degree of the problem. These responses can range from
minor changes in growth rate or cell attachment to
the total destruction of the culture. Determining if the
medium is responsible for a problem is relatively easy;
simply test the suspected batch against a sample proven
effective. Determining why the medium is defective is
extremely difficult due to the numerous reagents and
complex steps involved. Therefore, time and energy
are much better spent preventing media problems than
trying to find and fix them later; management by preven-
tion is the key to successful media production.
Problem Solving Suggestions
Many other problems can and will occur. Below are
some recommended steps that can be used to help iden-
tify cell culture problems and find their causes:
1.
Clearly identify and define the problem. It may
require additional testing to repeat or duplicate the
problem. It helps to make this a team effort, utilizing
everyone in the laboratory whose knowledge or
experience might contribute any helpful information.
2.
It often helps to break up complex problems into
smaller pieces that can be handled and understood
more easily.
3.
Organize all known facts surrounding the problem.
Be specific, look for cause and effect relationships
and then discard all facts that clearly do not apply
and work with the rest. Don’t overlook the obvious.
A problem well stated is a problem half solved.
4.
Once there is a clear understanding of the problem,
begin looking for the cause. Try to avoid the urge to
fix problems by changing everything; it may worsen
the situation or mask the original problem.
5.
Brainstorm and search for all the possible causes.
Identify all changes that have occurred in the lab, in
the cultures, in media, solutions, etc. that may relate
to the problem. Good record keeping is essential for
this step. Then select the best possibilities and begin
to evaluate if they are actually contributing to the
problem. Be creative! This may require some testing
and experimentation.
6.
Determine and implement the best long-term solu-
tion, not only to fix the problem but also to minimize
or prevent any chance of a recurrence of the problem.
This will take very careful planning.
MANAGEMENT BY PREVENTIoN IS THE KEY
To SuCCESSFuL MEDIA PRoDuCTIoN
Vibration-induced
concentric ring pattern
in a 100mm dish.
find Complete Product listings at
vwr.com
or Call
1.800.932.5000
|
8
8
|
The
EssEntials
of
Tissue Culture
find Complete Product listings at
vwr.com
or Call
1.800.932.5000
|
9
Media PreParation & Filtration
growth factors

Media selection guide
VWR has gathered some of the biggest names in cell culture media in one place, so you can access the best products
available. Products include:
Antibiotics
Antibodies
Buffers, Buffered
Salines, & Reagents
Classical
Media
Growth
Factors
Sera
Specialty
Media
Transfection
Reagents
Abgent
a
AMRESCO
a
a
Enzo
a
BD
a
a
BioLegend
a
Diagnostic
Biosystems
a
a
EMD
a
a
a
a
a
G-Biosciences
a
a
a
GE Healthcare
a
GenScript
a
HiMedia
a
a
MP Biomedicals
a
a
a
KPL
a
Lonza
a
a
a
a
a
Mediatech
a
a
a
a
a
PAA
a
a
Polyplus
a
Rockland
a
Thermo Pierce
a
Trevigen
a
a
enhanCe your Vwr.CoM exPerienCe
Vwr Click-to-Chat allows you to get immediate answers to your questions. Just log in to vwr.com to find the
"Click-to-Chat" icon on ordering pages, information request pages, and Vwr Collection product pages. a live
customer service agent will be available to provide immediate answers to any of your questions.
find Complete Product listings at
vwr.com
or Call
1.800.932.5000
|
8
find Complete Product listings at
vwr.com
or Call
1.800.932.5000
|
9
Media PreParation & Filtration
media selection

Distributor
GE Healthcare
Distributor
GE Healthcare
Whatman
™
Klari-Flex
™
Bottle-top
Filtration system, GE Healthcare
•
Permanent vacuum hose connection increases throughput and convenience
•
Fast connection of filter to base decreases set-up time
•
Ergonomically designed, large bottle cap accommodates labeling information and
acts as a handle for safe transport of bottles
•
Drop-Connect technology ensures fail-safe unit placement in base and automatic
vacuum line connection
•
Smaller filter sizes (15 and 50mL units) are now available; contact your VWR Sales
Representative for more information
Receiver Capacity, mL
Pore Size, µm
Cat. No.
Pack of
Funnel/Bottle Filtration Units
250
0.22
CA97034-720
12/
118.29
500
0.22
CA97034-722
12/
173.84
1000
0.22
CA97034-724
12/
245.53
250
0.45
CA97034-726
12/
115.60
500
0.45
CA97034-728
12/
173.84
1000
0.45
CA97034-730
12/
245.53
Funnels Only
250
0.22
CA97034-732
12/
98.57
500
0.22
CA97034-734
12/
115.60
1000
0.22
CA97034-736
12/
184.60
250
0.45
CA97034-738
12/
98.57
500
0.45
CA97034-740
12/
115.60
1000
0.45
CA97034-742
12/
184.60
Sterile Bottles (Receivers) Only
250
—
CA97034-744
24/
494.99
500
—
CA97034-746
24/
116.49
1000
—
CA97034-748
24/
181.01
Accessories
Pedestal Stand
—
CA97034-752
1/
1327.12
Cradle Ring
—
CA97034-750
1/
368.30
F cus
nformation
Streamline your laboratory operations and improve
throughput with the Whatman Klari-Flex bottle top
filtration system. Designed for filter sterilization of
liquids such as cell culture media, biological fluids
and buffers, the Klari-Flex system includes a stable,
low-profile pedestal base with a permanent vacuum
hose connection. This feature eliminates a time-
consuming and inconvenient step in your process
— connecting and disconnecting the vacuum
to each filter unit. With Klari-Flex, connect the
vacuum once to the pedestal base. Each time
a new filtration unit is placed on the base,
Drop-Connect technology ensures that the
vacuum connection is automatic.
Ergonomically designed
bottle and bottle cap
improve handling
Large 90 mm filter
membrane (500 and
1000 mL units) optimizes
performance
Simple one hand
operation connects
unit to base
Front-facing funnel
graduation marks
enhance readability
Weighted pedestal base
is built for stability
find Complete Product listings at
vwr.com
or Call
1.800.932.5000
|
10
10
|
The
EssEntials
of
Tissue Culture
find Complete Product listings at
vwr.com
or Call
1.800.932.5000
|
11
Media PreParation & Filtration
filtration

Polystyrene bottle-top
design has molded
graduations
Unit attaches directly
to media bottle
Support plate
minimizes
foaming and
eliminates
need for separate
filter pad
Quick-disconnect
sidearm accepts
1
/
4
–
3
/
8
" tubing
nalgene
®
MF75
™
Vacuum Filter
Units, thermo scientific
•
Ideal for biological and pharmaceutical sterilization
requirements
•
Choose from either a Supor
®
machV or standard
polyethersulfone membrane
•
Supor machV membranes are extremely clean,
low-extractable, fast-flowing, and asymmetric for
excellent throughput and low protein binding
•
Membranes with a 0.1μm pore size protect against
mycoplasma contamination
•
Filters have side arms fitted with quick-disconnect
tubing adapters and graduated upper chambers
•
Units are radiation sterilized; certified noncytotoxic
and nonpyrogenic
nalgene
®
MF75
™
Bottle-
top Vacuum Filter Units,
thermo scientific
•
Surfactant-free cellulose acetate (SFCA) membrane
filters are much cleaner than standard cellulose
acetate
•
Membranes are designed for use with glass media
bottles
•
Polystyrene filter design features molded graduation
and a support plate that minimized foaming
•
Quick-disconnect sidearm accepts
1
/
4
-
3
/
8
" tubing
•
Units are radiation sterilized
•
Units are radiation sterilized; certified noncytotoxic
and nonpyrogenic
Receiver
Capacity, mL
Pore Size,
µm
Membrane
Dia., mm
Cat. No.
Case of
Complete Units with Supor machV PES Membrane
115
0.2
50
73520-980
72/
482.98
150
0.2
50
73520-982
12/
75.51
250
0.2
50
73520-988
12/
97.78
500
0.2
75
73520-984
12/
164.81
500
0.2
90
73520-990
12/
137.23
1000
0.2
90
73520-986
12/
221.63
Complete Conical Filter Unit with Supor machV PES Membrane
50
0.2
50
82030-938
12/
69.61
Complete Units with Standard PES Membrane
150
0.1
50
97014-830
12/
73.75
250
0.1
50
97014-832
12/
95.90
500
0.1
75
97014-834
12/
161.10
115
0.45
50
28199-048
72/
459.32
150
0.45
50
16211-053
12/
88.00
250
0.45
50
16211-061
12/
115.07
500
0.45
75
16211-054
12/
191.30
500
0.45
90
16211-064
12/
186.76
1000
0.45
90
16211-056
12/
264.97
Capacity, mL
Membrane
Diameter, mm
Fits Neck
Size, mm
Cat. No.
Case of 12
Membrane with 0.2 µm Pore Size
150
50
33
28199-296
84.08
150
50
45
28199-300
84.08
500
75
33
28199-303
117.79
500
75
45
28199-307
117.79
1000
90
33
28199-312
188.07
1000
90
45
28199-317
188.07
Membrane with 0.45 µm Pore Size
150
50
33
28199-298
84.08
150
50
45
28199-302
84.08
500
75
33
28199-305
117.79
500
75
45
28199-309
117.79
find Complete Product listings at
vwr.com
or Call
1.800.932.5000
|
10
find Complete Product listings at
vwr.com
or Call
1.800.932.5000
|
11
Media PreParation & Filtration
filtration

health&well-being
12
12
Join Us in Building a Stronger
For every
VWR Collection
product you buy, a percentage*
of sales will be donated to the VWR Foundation, which
awards grants to research, science education, and health
and well-being programs.
The
VWR Collection
is an exclusive line of products that delivers the quality
and value you’ve come to trust from VWR. Now, every product in this line
has the potential to make a difference in someone’s life.
To read about the recipients of VWR Foundation grants, and to find out
more about the Foundation’s mission, visit
www.vwrfoundation.org
research
research
health&well-being
health&well-being
education
research
science education
science education
science education
science education
science education
science education
science education
science education
research
research
research
research
research
research
health&well-being
health&well-being
health&well-being
health&well-being
research
research
Foundation
for Science
*Vwr International, llC will contribute .15% of all Vwr Collection sales in the u.s., up to $350,000 annually, to the Vwr foundation. Vwr International Co., Vwr International, llC’s Canadian subsidiary, will donate .15% of all Vwr
Collection sales in Canada, up to $35,000 annually, to the hospital for sick Children foundation (sickKids). Vwr International, llC, Vwr International Co., and/or the Vwr foundation reserve the right to end this program without notice.
health&well-being
find Complete Product listings at
vwr.com
or Call
1.800.932.5000
|
13

research
research
health&well-being
health&well-being
science education
science education
science education
science education
science education
health&well-being
Foundation
for Science
VWR
®
Vacuum Filtration systems
•
System incorporates a large membrane area and low center of
gravity for fast sample processing
•
Polyethersulfone (PES) membrane offers fast liquid flow rates and
low protein binding
•
Funnel base and cap feature convenient finger tabs
•
Sterilized by gamma radiation
Receiver Capacity, mL
Cat. No.
Pack of 12
Systems with 0.2 μm PES Membrane
150
/250
CA87006-062
106.78
500
CA87006-064
143.95
1000
CA87006-066
179.06
Systems with 0.45 μm PES Membrane
150
/250
CA87006-068
131.28
500
CA87006-070
144.57
1000
CA87006-072
176.96
Vacuum Filter/storage
systems, Corning
•
Ideal for tissue culture solution, biological fluids,
or other aqueous solutions
•
Units feature stable profile reciever bottle with
easy-grip sides and angles hose adapter to
minimize tipping
•
Receiver converts to storage bottle by replacing
the filter with a sterile plug seal cap
•
Pore size and membrane type are printed on
each unit
•
Sterilized by gamma radiation; certified
nonpyrogenic
VWR
®
syringe Filters
•
Ideal for sterile filtration of buffers, tissue culture
media or additives, and other biologicals
•
Polyethersulfone filters offer high flow rates
•
Features male Leur slip and female Leur-lock
connections
•
Acrylic housing
•
Biosafe according to Class VI plastics tests
•
ISO 9001 certified
•
Diameter
..
25mm (1")
Pore Size, μm
Cat. No.
Pack of
Cellulose Acetate Membrane Filters
0.2
CA28145-477
50/
60.49
0.2
CA28145-475
100/
209.08
0.45
CA28145-481
50/
58.80
0.45
CA28145-479
100/
209.08
Polyethersulfone Membrane Filters
0.2
CA28145-501
50/
67.49
0.2
CA28145-499
100/
120.97
0.45
CA28145-505
50/
196.15
0.45
CA28145-503
100/
177.94
Pore Size, µm
Filtration Area, cm
2
Funnel Cap, mL
Cat. No.
Case of 12
Polyethersulfone Membrane
0.22
13.6
150
29442-936
84.55
0.22
19.6
250
28199-764
94.58
0.22
33.2
500
28199-778
156.18
0.22
54.5
1000
28199-792
232.11
Cellulose Acetate Membrane
0.22
13.6
150
29442-938
87.08
0.22
19.6
250
28199-774
94.45
0.22
33.2
500
28199-788
160.86
0.22
54.5
1000
28199-812
237.63
0.45
13.6
150
29442-940
87.08
0.45
19.6
250
28199-776
87.04
0.45
33.2
500
29552-016
160.86
0.45
54.5
1000
28199-814
237.63
Cellulose Nitrate Membrane
0.2
33.2
500
28199-784
159.40
0.2
54.5
1000
28199-798
234.68
Nylon Membrane
0.2
33.2
500
28199-780
169.72
0.2
54.5
1000
28199-794
249.48
disCoVer
More ChoiCes
with Vwr
Visit vwr.com to browse our
selection of catalogs and
technical data. you’ll find
the information you need at
your fingerstips. Vwr’s fast,
powerful search capabilities
allow you to "search" or use
"more options" for more
advanced lookups.
find Complete Product listings at
vwr.com
or Call
1.800.932.5000
|
13
Media PreParation & Filtration
filtration

F cus
nformation
treated Cell Culture Flasks, Corning
•
Treated for optimum cell attachment and growth
•
Lot number is printed on flasks for traceability
•
Sterilized with gamma irradiation; certified nonpyrogenic
Growth Area, cm
2
Neck Style
Cat. No.
Case of
Phenolic-Style Polyethylene Caps
162
Straight
29442-024
25/
139.16
225
Canted
29442-014
24/
178.58
Vented-Style Polyethylene Caps
162
Straight
29442-004
25/
137.34
225
Canted
29442-000
24/
176.00
In the race to bring new drugs,
therapies, and vaccines to market, you
rely on innovative tools that make
your research more cost-effective and
efficient. Corning’s leading-edge, quality
scale-up and bioprocess product can
help you improve productivity while
keeping an eye on the bottom line.
Their flask and vessel options
will help you move quickly from
R&D to production.
Corning
®
Polystyrene tissue Culture Flasks
•
Treated for optimum cell attachment and growth
•
Triangular flasks provide increased stability and better pipet access
•
Canted-neck flasks feature a skirt to prevent tipping
•
Plug seal caps can be used in open and closed systems
•
Vented caps allow efficient gas exchange and minimize contamination
•
Lot numbers are printed on the flasks for easy traceability
•
Sterilized with gamma irradiation; certified nonpyrogenic
Growth Area, cm
2
Neck Style
Cap Type
Packaging
Cat. No.
Case of
Triangular Flasks
25
Angled
Phenolic
20/Sleeve
29442-020
500/
761.84
25
Angled
Vented Filter
10/Sleeve
29442-002
200/
376.97
75
Straight
Phenolic
5/Sleeve
29442-028
100/
340.85
75
Straight
Vented Filter
5/Sleeve
29442-008
100/
344.78
Rectangular Flasks
25
Canted
Plug
20/Sleeve
29186-002
500/
776.02
25
Canted
Phenolic
20/Sleeve
29186-024
500/
776.02
25
Canted
Vented Filter
20/Sleeve
29186-010
200/
342.15
75
Canted
Plug
5/Sleeve
29186-080
100/
320.58
75
Canted
Phenolic
5/Sleeve
29186-104
100/
320.58
75
Canted
Vented Filter
5/Sleeve
29186-105
100/
326.07
100
Canted
Vented Filter
6/Sleeve
89089-710
60/
196.63
150
Canted
Plug
5/Sleeve
29186-160
50/
270.04
150
Canted
Phenolic
5/Sleeve
29186-192
50/
270.04
150
Canted
Vented Filter
5/Sleeve
29186-106
50/
265.25
175
Angled
Plug
5/Sleeve
89090-948
50/
277.93
175
Angled
Phenolic
5/Sleeve
29560-969
50/
282.49
175
Angled
Vented Filter
5/Sleeve
89090-950
50/
273.89
175
Angled
Vented Filter
7/Sleeve
10010-366
84/
533.49
225
Angled
Plug
5/Sleeve
29186-199
50/
181.68
225
Angled
Vented Filter
5/Sleeve
29560-959
25/
183.42
CellBinD
®
Flasks, Corning
•
CellBIND surface treatment incorporates more oxygen into the surface,
making the surface more stable
•
Surfaces are nonbiological and require no special handling or storage
•
Sterilized with gamma irradiation; certified nonpyrogenic
Growth
Area, cm
2
Neck Style
Cap Type
Cat. No.
Case of
Low Profile Flasks
100
Canted
Vented
89089-832
60/
305.95
Standard Flasks
25
Canted
Vented
46610-076
200/
413.69
75
Canted
Vented
46610-078
100/
388.71
150
Canted
Vented
46610-080
50/
319.71
175
Angled
Phenolic
22250-136
50/
328.52
175
Angled
Vented
46610-082
50/
332.61
225
Angled
Vented
46610-084
25/
217.43
Standard Flasks with Bar Code
175
Angled
Vented
22250-134
84/
660.61
Cell CultiVation
general flasks, Plates, dishes
find Complete Product listings at
vwr.com
or Call
1.800.932.5000
|
14
14
|
The
EssEntials
of
Tissue Culture
find Complete Product listings at
vwr.com
or Call
1.800.932.5000
|
15

CEllstaR
®
tissue Culture Flasks, Greiner Bio-One
•
Canted-neck flasks are manufactured in an asceptic, fully automated facility
•
Made from high-quality virgin polystyrene resin for optical clarity
•
Adherent flasks are tissue-culture treated
•
All 550mL flasks feature a low-profile design; all 650mL flasks feature a high-profile design
•
Sterilized by gamma radiation
Volume, mL
Growth Area, cm
2
Cap Type
Cat. No.
Case of
Adherent Flasks
50
25
Filter
82051-074
200/
201.12
50
25
Plug
82051-070
200/
178.60
250
75
Filter
82050-856
120/
245.91
250
75
Plug
82050-854
120/
223.94
550
175
Filter
82050-872
50/
179.08
550
175
Plug
82050-870
50/
149.18
650
175
Filter
82050-878
40/
141.76
650
175
Plug
82050-876
40/
134.10
Suspension Flasks
50
—
Filter
82051-078
200/
164.12
50
—
Plug
82051-076
200/
148.90
250
—
Filter
82050-860
120/
196.61
250
—
Plug
82050-858
120/
134.16
550
—
Plug
82050-874
50/
139.66
650
—
Filter
82050-882
40/
114.83
650
—
Plug
82050-880
40/
107.34
Polystyrene Cell Culture
Flasks, Corning
•
Constructed from optically clear virgin
polystyrene
•
Untreated flasks are printed with lot
numbers for easy traceability
•
Feature a canted neck and vented cap
•
Sterilized with gamma irradiation;
certified nonpyrogenic
Growth Area, cm
2
Cat. No.
Case of
25
89092-698
200/
319.74
75
89092-700
100/
300.75
150
89092-702
50/
254.31
175
89092-704
50/
264.01
RoboFlask
™
Cell Culture Vessels, Corning
•
For use in manual or automated protocols
•
Feature a standard microplate footprint and bar code
•
Polystyrene surfaces are treated for tissue culture
•
Growth area
..
96.2cm
2
•
Sterilized with gamma irradiation; certified nonpyrogenic
Neck Style
Cap Type
Packaging
Cat. No.
Case of
Standard Tissue Culture-Treated Vessels
Straight
Flat
10/Sleeve
22250-130
50/
263.10
Straight
Flat
20/Sleeve
22250-126
100/
518.24
Straight
Septum
10/Sleeve
22250-128
50/
263.10
Straight
Septum
20/Sleeve
89089-874
100/
512.84
CellBIND
®
-Treated Vessels
Short
Septum
20/Sleeve
89089-852
100/
657.98
CellBinD
®
Multiwell
Plates, Corning
•
Surface treatment improves cell attachment by
incorporating more oxygen into the cell culture
surface
•
CellBIND surfaces are nonbiological and require no
special handling or storage
•
Plates are made from virgin polystyrene and feature
clear, flat bottoms
•
Round-bottom wells have individual alphanumeric
codes for easy identification
•
Supplied with nonreversible lid with condensation
rings to reduce contamination
•
Sterilized by gamma radiation; certified nonpyrogenic
No. of Wells
Well Volume, mL
Cell Growth Area, cm
2
Cat. No.
Case of 50
6
16.8
9.5
22250-140
141.24
24
3.4
1.9
22250-144
178.96
bdh now oFFers MoleCular
biology grade CheMiCals
The quality you've come to expect from bdh is now available for molecular biology
applications. Contact your Vwr Chemical specialist for more information.
find Complete Product listings at
vwr.com
or Call
1.800.932.5000
|
14
Cell CultiVation
general flasks, Plates, dishes
find Complete Product listings at
vwr.com
or Call
1.800.932.5000
|
15

CEllstaR
®
tissue Culture Plates, Greiner Bio-One
•
Chimney well plates reduce the possibility of cross-contamination
•
Individual well rims rise above the surface of the plate to aid in sealing by cap mat, thermal sealer, or adhesive sealer
•
Excellent heat exchange during incubation is ensured through air circulation spaces between stacked plates
•
384-well plates feature a rounded square well top to minimize wicking, yet provide increased surface area
•
Plates feature flat-bottom wells
•
DNase-, RNase-, and human-DNA free
•
Sterilized by gamma radiation; noncytoxic and nonpyrogenic
No. of Wells
Working Well Volume
Lid Type
Packaging
Cat. No.
Case of
6
2–5 mL
with Condensation Rings
Individually Wrapped
82050-842
100/
146.23
6
2–5 mL
with Condensation Rings
5/Sleeve, 24 Sleeves/Case
82050-844
120/
170.98
12
2–4 mL
with Condensation Rings
Individually Wrapped
82050-930
100/
175.32
12
2–4 mL
with Condensation Rings
5/Sleeve, 24 Sleeves/Case
82050-928
120/
206.21
24
0.5–1.5 mL
with Condensation Rings
Individually Wrapped
82050-892
100/
182.94
24
0.5–1.5 mL
with Condensation Rings
5/Sleeve, 24 Sleeves/Case
82050-894
120/
215.38
48
0.5–1 mL
with Condensation Rings
Individually Wrapped
82051-004
100/
230.28
48
0.5–1 mL
with Condensation Rings
5/Sleeve, 24 Sleeves/Case
82051-002
120/
271.79
96
25–340 µL
with Condensation Rings
Individually Wrapped
82050-771
100/
145.50
96
25–340 µL
with Condensation Rings
10/Sleeve, 16 Sleeves/Case
82051-596
160/
358.27
96*
25–340 µL
Black, Standard
8/Sleeve, 4 Sleeves/Case
89135-048
32/
217.54
384
10–130 µL
Clear, Standard
8/Sleeve, 4 Sleeves/Case
82051-304
32/
95.01
384*
10–130 µL
Black, Standard
8/Sleeve, 4 Sleeves/Case
82051-282
32/
198.74
*Plates feature µClear
®
bottoms for clear viewing and minimized autofluorescence.
improved surfaces for different Cell Culture applications
Classical applications in cell biology such as the cultiva-
tion and manipulation of immortalized cells in adherent
and suspension culture became standard practice in
laboratories around the world.
With the CELLSTAR
®
product line, Greiner Bio-One
offers the ultimate solution for these classical and
standard cell culture techniques. Featuring high quality
and reliability through the use of virgin ultrapure, non-
cytotoxic polymers, CELLSTAR
®
products are available
in a broad spectrum of formats that covers the entire
range of applications in cell biology, including the
propagation of cells, performance of cell-based assays,
and elementary imaging procedures.
An essential requirement for culturing cells in vitro is a
surface substrate that provides a basis for firm attach-
ment of anchorage-dependent cells under in vitro culture
conditions. Besides physically treated culture vessels,
protein-coated culture vessels are widely used in cell
culture to increase cell adhesion, differentiation, vitality,
and proliferation.
Two types of proteins/polypeptides are used to coat
polystyrene surfaces for this purpose.
•
Extracellular matrix proteins – like Collagen Type I,
Fibronectin, and Laminin – mediate specific binding of
the cell to the protein.
•
Fibronectin and Laminin exhibit a binding sequence –
the R-G-D (Arg-Gly-Asp) motif – known to bind to
the integrin receptor of the cell. This heterodimeric cell
surface adhesion receptor not only regulates binding
between cell and substrate, it also triggers signaling
pathways that direct cellular processes such as prolif-
eration, survival, differentiation, and migration.
Greiner Bio-One offers coated surfaces with natural pro-
teins and synthetic polypeptides – like Collagen Type I,
Fibronectin, Laminin, and Poly-Lysine for the cultivation
of specific cell lines and various experimental procedures.
Poly-D-Lysine, a synthetically produced biomolecule,
belongs to the non-specific adhesion-promoting poly-
peptides. Poly-Lysine enhances the attachment of cells
by generating a positive charge on the surface and is
frequently used to promote cell adhesion.
The applications in Poly-Lysine-coated culture vessels
include the integration of washing steps in an experi-
mental setup, the cultivation of cells under serum-free
or serum-reduced conditions, or the transfection of cells.
It has been proven that Poly-D-Lysine (PDL)-coated
surfaces provide beneficial advantages when culturing
neuronal cell lines with respect to both viability and
proliferation.
For the cultivation of fastidious cells or cells cultivated
under restricted growth conditions, Greiner Bio-One also
offers the Advanced TC
™
polymer modification. Based on
an innovative physical treatment, the cell culture surface
is modified to positively influence cellular features and
functions and improve cell adherence for optimal growth
conditions. Even embryonic stem cell cultivation can be
completed without any risk of cross-contamination and
pathogen spreading caused by feeder cells or biological
coatings. In addition to the positive effects during general
cell propagation, Advanced TC
™
also supports neuronal
differentiation and long term cultivation.
es-d3 cell line has been
cultivated on advanced
TC
™
surface in lIf con-
taining stem cell media.
4 days after seeding
expression of the
surface marker ssea-1
(a) and transcription
factor oct-4 (b) has
been analyzed using
a mouse-anti-ssea-1
or rabbit-anti-oct-4
antibody detected by
the respective alexa
488 coupled secondary
antibody and a daPI
counter stain.
Cell CultiVation
general flasks, Plates, dishes
find Complete Product listings at
vwr.com
or Call
1.800.932.5000
|
16
16
|
The
EssEntials
of
Tissue Culture
find Complete Product listings at
vwr.com
or Call
1.800.932.5000
|
17

CellBinD
®
Culture Dishes, Corning
•
CellBIND surface treatment improves cell attachment by incorporating more oxygen
into the cell culture surface
•
Surfaces are nonbiological and require no special handling or storage
•
Petri-style, disposable polystyrene dish features vents to allow consistent gas
exchange
•
Stacking beads assist in handling
•
Sterilized by gamma radiation; certified nonpyrogenic
Dia. x H, mm
Growth
Area, cm
2
Growth
Surface, mm
Cat. No.
Case of 40
100 x 20
55
83.8
89089-840
63.43
CEllstaR
®
tissue Culture Dishes, Greiner Bio-One
•
Polystyrene plates are treated for optimal cell attachment and proliferation
•
Vented for uniform gas exchange
•
Nonpyrogenic, RNase-, and DNase-free
Dia. x H, mm
Growth Area, cm
2
Cat. No.
Case of
35 x 10
8.7
82050-538
740/
250.82
60 x 15
21
82050-546
600/
225.46
94 x 16
58
82050-580
480/
343.64
100 x 20
58
82050-916
360/
284.07
145 x 20
145
82050-598
120/
180.49
Corning
™
tissue Culture Dishes
•
Specially treated for optimal growth of anchorage dependent cells
•
Vents are designed for consistent gas exchange in open culture procedures
•
Disposable polystyrene dishes are sterilized by gamma radiation
•
Certified nonpyrogenic
Dia. x H, mm
Growth Area,
cm
2
Growth
Surface, mm Packaging
Cat. No.
Case of
Round Dishes
35 x 10
8
33.9
20/Sleeve
25382-348
500/
266.10
60 x 15
21
51.4
20/Sleeve
25382-392
500/
395.18
60 x 15
21
51.4
10/Sleeve
25382-381
500/
310.03
100 x 20
55
80.5
20/Sleeve
25382-428
500/
665.26
100 x 20
55
80.5
10/Sleeve
25382-439
480/
637.32
150 x 25
148
138.7
5/Sleeve
25382-442
60/
156.14
Square Dishes
245 x 25
500
224
4/Sleeve
29186-489
16/
280.46
vWr
CaTalysT is an industry-specific, services and solutions provider for research
and scientific labs, as well as high-tech production environments. for more than
two decades, we have focused exclusively on providing excellence in services for
your core business. Contact your Vwr sales representative or call
1.888.793.2300
for more information on how we can help you run your business better.
Powering Productivity. Delivering Results.
find Complete Product listings at
vwr.com
or Call
1.800.932.5000
|
16
Cell CultiVation
general flasks, Plates, dishes
find Complete Product listings at
vwr.com
or Call
1.800.932.5000
|
17

nunclon
™
Δ MultiDishes, thermo scientific
•
Flat-bottom wells are treated with Nunclon Δ surface treatment for optimal cell attachment and growth
•
Rings in the lids reduce evaporation and condensation
•
Writing areas on lids and dishes and individual alphanumeric markings allow easy identification of samples
•
Sterile, noncytotoxic, and nonpyrogenic
No. of Wells
Well Area, cm
2
Working Volume, mL
External Dimensions, mm
Packaging
Cat. No.
Case of
4
1.9
0.4–1.0
66 x 66
4/Sleeve
CA62407-068
120/
267.37
6
9.6
2.0–5.0
128 x 86
1/Sleeve
CA73520-906
75/
194.03
6
9.6
2.0–5.0
128 x 86
5/Sleeve
CA73520-836
85/
214.17
12
3.5
0.7–1.8
128 x 86
1/Sleeve
CA62407-332
75/
219.75
24
1.9
0.4–1.0
128 x 86
1/Sleeve
CA73521-004
75/
243.23
24
1.9
0.4–1.0
128 x 86
5/Sleeve
CA73521-006
85/
269.23
48
1.1
0.3–0.6
128 x 86
1/Sleeve
CA62407-338
75/
292.39
48
1.1
0.3–0.6
128 x 86
5/Sleeve
CA73521-008
85/
320.29
The Nunclon
™
Δ polystyrene surface is certified for
monolayer formation with two different cell lines and
a primary cell culture. Cloning efficiency is performed
with a specially selected cell line that has a high
sensitivity to the presence of any toxic compounds.
F cus
nformation
nunclon
™
Δ Dishes, thermo scientific
•
High optical clarity dishes effectively support adherent cell lines
for research and industry
•
Top and bottom stacking rings provide easy handling
•
Sterile
Dimensions, mm
Growth Area,
cm
2
Bottom
I.D., mm
Dishes/
Sleeve
Cat. No.
Case of
Vented Dishes, with Grid
35 dia. x 10L
8.8
35
20
CA62407-124
500/
341.74
60 dia. x 15L
21.5
52
10
CA25382-336
400/
325.86
Vented Dishes, without Grid
35 dia. x 10L
8.8
33
10
CA25382-334
500/
290.53
60 dia. x 15L
20.5
51
10
CA25382-330
400/
263.52
100 dia. x 15L
56.7
136
10
CA25382-328
450/
564.63
100 dia. x 20L
56.7
86
10
CA62407-132
480/
611.78
140 dia. x 20L
145
136
10
CA25382-335
80/
229.07
Standard Unvented Dishes
35 dia. x 10L
8.8
33
10
CA25382-331
500/
289.59
60 dia. x 15L
18.1
48
10
CA25382-332
400/
262.59
245W x 245L x 25H
500
—
4
CA25382-327
16/
310.08
nunclon
™
Δ Rectangular Dishes, thermo scientific
•
Useful in all areas of cell culture, including scale-up and cloning
•
Ideal for compartmentalizing cell culture assays
•
Include lids
•
Feature ANSI standard dimensions for instrument compatibility
•
Sterile
Description
Total Well
Volume, mL
Working Well
Volume, mL
Cat. No.
Case of 100
4-Well Dish
28
12
CA73521-422
422.31
8-Well Dish
14
6
CA73521-426
440.95
nunclon
™
Δ MicroWell
™
terasaki-
style Plates, thermo scientific
•
Treated for enhanced cell attachment
•
Conical-shaped wells hold 8µL and allow for full
sample recovery
•
Tight-fitting lids reduce evaporation and allow
stable stacking
•
Sterilized by gamma irradiation
No. of Wells
Cat. No.
Case of 150
60
CA62409-106
214.70
72
CA62409-105
214.70
nunclon
™
Δ MicroWell
™
Plates, thermo scientific
•
Ideal for cell culture, cloning, viral titration, and cell fusion
•
Treated surface ensures optimum cell growth and attachment
•
96-well plates fit standard automated handling equipment
•
Raised well rims reduce cross-contamination
•
White plates provide maximum reflection and minimum autofluorescence
•
Black plates provide minimum background and back light scatter in
fluorescence assays
•
Sterilized by gamma irradiation
Plate Color
Packaging
Cat. No.
Case of
Round-Bottom Well Plates with Lids
Clear
1/Sleeve
CA25382-329
50/
216.27
Flat-Bottom Well Plates with Lids
Clear
1/Sleeve
CA25382-342
50/
217.20
Clear
10/Sleeve
CA21993-954
160/
599.61
Black
1/Sleeve
CA43300-444
50/
222.76
Black
10/Sleeve
CA43300-446
160/
661.79
White
1/Sleeve
CA43300-430
50/
222.76
White
10/Sleeve
CA46000-328
160/
661.79
Round-Bottom Well Plates without Lids
Clear
1/Sleeve
CA25382-340
50/
150.37
Flat-Bottom Well Plates without Lids
Clear
1/Sleeve
CA25382-341
50/
175.45
Clear
10/Sleeve
CA21993-952
180/
540.21
Cell CultiVation
general flasks, Plates, dishes
find Complete Product listings at
vwr.com
or Call
1.800.932.5000
|
18
18
|
The
EssEntials
of
Tissue Culture
find Complete Product listings at
vwr.com
or Call
1.800.932.5000
|
19

CEllCOat
®
Protein Coated
Flasks, Greiner Bio-One
•
Coated with extra-cellular matrix proteins (ECM) or synthetic
peptides that stimulates the cell’s natural environment
•
Flasks feature a canted neck, plug seal, "Best Before" date, and a
lot number on each pack
•
650mL flasks feature a high profile design
•
Certified nonpyrogenic and DNase- and RNase-free
•
Sterile
CEllCOat
®
tissue Culture
Plates, Greiner Bio-One
•
Poly-D-Lysine coating enhances the attachment of cells by
generating a positive charge on the plate surface
•
Surface is ideal for culturing neuronal cell lines or cell transfection
•
Plates feature a "Best Before" date and lot number
•
Footprint conforms to ANSI/SBS 1-2004 standard
•
Clear plates are supplied with lids
No. of
Wells
Working
Well Volume Lid Color Packaging
Cat. No.
Case of
6
2–5 mL
Transparent
5/Sleeve,
10 Sleeves/Case
82050-850
50/
419.17
24
0.5–1.5 mL
Transparent
5/Sleeve,
10 Sleeves/Case
82050-906
50/
451.42
96
30–340 µL
Black
5/Sleeve,
4 Sleeves/Case
82050-806
20/
319.00
384
10–130 µL
Black
5/Sleeve,
4 Sleeves/Case
82051-358
20/
458.88
Volume, mL
Growth Area, cm
2
Cat. No.
Case of
Poly-D-Lysine Coating
250
75
82050-862
50/
471.64
Collagen Type 1 Coating
250
75
82050-864
50/
451.12
650
175
82050-886
40/
708.50
Corning
®
Osteo assay surface Plates
•
Surface is a unique 3-D structure that mimics in vivo bone
•
Inorganic surface is capable of supporting the functional properties of osteogenic cells
•
Use for direct assessment of osteoclast and osteoblast functional activity
•
Allows for co-culture of osteoblast/osteoclasts with other cell lines
•
Sterilized with gamma irradiation; certified nonpyrogenic
Description
Cat. No.
Case of
1 x 8 Stripwell
®
Microplate with Lid*
89184-614
2/
360.94
*12 Strips/Holder
CO
NH-P
eptide
CO
NH-P
eptide
CO
NH-P
eptide
CO
NH-P
eptide
CO
NH-P
eptide
Synthemax surface is a unique synthetic coating on tissue
culture-treated cell culture ware. The surface chemistry
is designed to mimic a cell’s natural environment.
The coating is a peptide acrylate (see Figure 1)
that creates a uniform active surface for stem cell
attachment, growth, and differentiation, especially
in a chemically defined media. Cells grown on the
Synthemax surface display stable double times
and excellent viability.
F cus
nformation
figure 1: Peptide acrylate surface
Corning
®
synthemax
™
-R surface
Sythemax Surface Characteristics
•
Synthetic, xeno-free substrate
•
Ready-to-use, no preparation required
•
Manufacturing process ensure lot-to-lot consistency
•
Sterilized by gamma radiation to (SAL) 10
-3
Description
Cat. No.
Case of
6-Well Plate
89166-460
2/
60.52
6-Well Plate
89166-462
12/
357.68
75 cm
2
Flask with Canted Neck and Vent Cap
89168-660
2/
79.23
75 cm
2
Flask with Canted Neck and Vent Cap
89168-662
12/
473.23
find Complete Product listings at
vwr.com
or Call
1.800.932.5000
|
18
find Complete Product listings at
vwr.com
or Call
1.800.932.5000
|
19
Cell CultiVation
specialty surface flasks, Plates, dishes

BD BioCoat
™
Cultureware, BD Biosciences
The Right Surface for Every Cell
With more than 50 years of research heritage, BD Biosciences - Discovery
Labware is the leading provider of cell culture surfaces, including BD Bio-
Coat
™
proven to facilitate, accelerate, and enhance discovery.
•
Offers improved cell attachment and an increased proliferation rate of transfected
mammalian cells, primary cells, and stem cells
•
Tested negative for bacteria and fungi
•
Quality assurance tested for lot-to-lot consistency
•
Stable for six months from date of shipment when stored at room temperature
•
Collagen Type I is good with endothelial cell, epithelial cells, hepatocytes, and
tumor cells
•
Collagen Type IV promotes the growth of endothelial, epithelial, muscle,
and nerve cells
•
Fibronectin promotes cell attachment through integrin binding and improves
survival of primary cells
•
Laminin is used to culture and maintain differentiated functions in neuroblastoma
and breast cancer cells
•
Poly-lysine promotes firm attachment of transfected and primary cells
Description
Cat. No.
Case of
Collagen Type I Cultureware
60 mm Dish
CACB354401
20/
91.31
100 mm Dish
CA-CB354450
10/
104.33
6-Well Plate
CA-CB354400
5/
93.30
12-Well Plate
CA-CB354500
5/
100.48
24-Well Plate
CA-CB354408
5/
97.08
48-Well Plate
CA-CB354505
5/
135.99
96-Well Plate
CA-CB354407
5/
99.06
Collagen Type IV Cultureware
60 mm Dish
CA-CB354416
20/
186.00
100 mm Dish
CA-CB354453
10/
206.36
6-Well Plate
CA-CB354428
5/
196.47
24-Well Plate
CA-CB354430
5/
200.42
96-Well Plate
CA-CB354429
5/
206.36
Fibronectin Cultureware
60 mm Dish
CA-CB354403
20/
165.01
100 mm Dish
CA-CB354451
10/
186.58
6-Well Plate
CA-CB354402
5/
170.76
12-Well Plate
CA-CB354501
5/
179.37
24-Well Plate
CA-CB354411
5/
174.53
48-Well Plate
CA-CB354506
5/
184.59
96-Well Plate
CA-CB354409
5/
180.27
Laminin Cultureware
60 mm Dish
CA-CB354405
20/
186.00
100 mm Dish
CA-CB354452
10/
206.36
6-Well Plate
CA-CB354404
5/
189.83
12-Well Plate
CA-CB354502
5/
198.45
24-Well Plate
CA-CB354412
5/
193.65
48-Well Plate
CA-CB354507
5/
204.37
96-Well Plate
CA-CB354410
5/
199.38
Poly-D-Lysine Cultureware
60 mm Dish
CA-CB354468
20/
94.51
100 mm Dish
CA-CB354469
10/
104.33
6-Well Plate
CA-CB354413
5/
93.30
12-Well Plate
CA-CB354470
5/
100.48
24-Well Plate
CA-CB354414
5/
97.08
48-Well Plate
CA-62406-279
5/
127.57
96-Well Plate
CA-CB354461
5/
102.52
Poly-L-Lysine Cultureware
60 mm Dish
CA62406-268
20/
91.34
6-Well Plate
CA62406-280
5/
89.71
96-Well Plate
CA62406-276
5/
96.93
F cus
nformation
Extracellular Matrix (ECM) proteins provide
a range of diverse options that allow
you to mimic in vivo environments
and maximize cellular activity. BD
™
ECM proteins are highly purified and
defined so that you can grow your
cells under more defined serum-
reduced or serum-free conditions.
BD B
i
osc
i
ences
For additional BioCoat cultureware products, contact your VWR Sales Representative.
find Complete Product listings at
vwr.com
or Call
1.800.932.5000
|
20
20
|
The
EssEntials
of
Tissue Culture
find Complete Product listings at
vwr.com
or Call
1.800.932.5000
|
21
Cell CultiVation
specialty surface flasks, Plates, dishes

Costar
®
Center Well Culture Dish, Corning
•
Designed in consultation with embryologists and researchers for
IVF procedures
•
Center well has a 20mm dia. and holds 3mL of medium for oocyte
culture and insemination
•
Outer well holds 10mL of medium for humidification
•
Treated for optimal cell attachment
•
Sterilized by gamma radiation; certified nonpyrogenic
Dia. x H, mm
Growth Area, cm
2
Cat. No.
Case of 500
60 x 15
3.14
29442-026
1194.43
advanced tC
™
tissue
Culture Plates,
Greiner Bio-One
•
Use for the cultivation of fastidious and
sensitive cells
•
Unique chemical modification of plastic
material increases primary and long-
term adhesion of cell cultures
•
Enhanced cell attachment and higher
proliferation rates offer increased cell yield
•
Allows for improved assay consistency
•
Store at room temperature for up to
two years
•
Sterilized by gamma radiation
No. of
Wells
Lid Color
Packaging
Cat. No.
Case of
6
Transparent
Individually
Wrapped
89131-688
100/
234.07
12
Transparent
Individually
Wrapped
89136-864
100/
264.27
24
Transparent
Individually
Wrapped
89131-690
100/
286.92
48
Transparent
Individually
Wrapped
89136-866
100/
317.13
96
Transparent
Individually
Wrapped
89131-692
100/
377.53
96*
Black
8/Sleeve, 4
Sleeves/Case
89131-694
32/
226.52
*Plate features µClear
®
bottoms for clear viewing and minimized autofluorescence.
F cus
nformation
Ultra-low attachment surface from Corning
Since proteins and other biomolecules passively adsorb
to polystyrene surfaces through either hydrophobic or
ionic interactions, researchers at Corning set out to
create a surface that naturally inhibits these interactions.
The result was a covalently-bound hydrogel layer that
inhibits cell attachment. The surface is very stable,
noncytotoxic, biologically inert, and nondegradable.
figure 1: Corning ultra-low attachment
surface inhibits differentiation and pro-
motes tight well-defined embryoid body
formation in murine es cell grown in
methylcellulose medium for 3 days
The Ultra-Low Attachment Surface is Useful for:
•
Growing primary cultures of tumor or normal cells as unattached spheroids
•
Studying activation and inactivation mechanisms of lymphocytes, monocytes,
macrophages, and other phagocytic cells
•
Selectively culturing tumor or transformed cells as unattached colonies
•
Culturing cells, tissue, or organ fragments in a stationary suspended, unattached state
•
A substitute for soft agar assays
•
Tissue engineering of easily harvested cell sheets and constructs using magnetic
nanoparticles or liposomes
•
Promoting embryoid body formation (see Figure 1)
•
Growing colonies with defined margins
•
Harvesting individual colonies quickly and easily
Description
Cat. No.
Case of
6-Well Flat-Bottom Plate
29443-030
24/
324.96
24-Well Flat-Bottom Plate
29443-032
24/
337.43
96-Well Flat-Bottom Plate
29443-034
24/
393.88
96-Well Round-Bottom Plate
89089-826
24/
398.51
25 cm
2
Flask with Canted Neck and Vent Cap
89089-876
24/
351.07
75 cm
2
Flask with Canted Neck and Vent Cap
89089-878
24/
491.65
60 mm Culture Dish
33500-730
20/
247.06
100 mm Culture Dish
33500-732
20/
302.08
CEllCOat
®
Protein-Coated Petri Dishes, Greiner Bio-One
•
Dishes are coated with extracellular matrix proteins or synthetic polypeptides
•
Coatings provide scaffolding that participates directly and indirectly
in cell growth regulation and differentiation
•
A reliable alternative for application involving sensitive cells
•
Feature a "Best Before" date and lot number
•
Certified nonpyrogenic and DNase- and RNase-free
W x H, mm
Growth Area, cm
2
Cat. No.
Case of
Collagen Type I-Coated Dishes
60 x 15
21
82050-558
100/
298.16
100 x 20
58
82050-924
40/
215.73
Laminin-Coated Dishes
60 x 15
21
82050-550
20/
171.67
100 x 20
58
82050-920
10/
228.13
Poly-D-Lysine-Coated Dishes
60 x 15
21
82050-556
100/
347.84
100 x 20
58
82050-922
40/
215.73
Poly-L-Lysine-Coated Dishes
60 x 15
21
82050-554
100/
273.31
find Complete Product listings at
vwr.com
or Call
1.800.932.5000
|
20
find Complete Product listings at
vwr.com
or Call
1.800.932.5000
|
21
Cell CultiVation
specialty surface flasks, Plates, dishes

BD BioCoat
™
Matrigel
™
Matrix
Cultureware, BD Biosciences
•
BD Matrigel is rich in ECM proteins, especially collagen IV, entactin, heparin sulfate
proteoglycans, and laminin
•
Protein source is Engelbreth-Holm-Swarm mouse tumor
•
Offers lot-to-lot consistency and reliable performance
•
Tested for bacteria and fungi
•
Stable for ≥3 months from the date of shipment when stored frozen
Description
Cat. No.
Case of
Culture Dishes
35 mm
CA-CB354460
8/
423.90
Thin Layer Culture Dishes
35 mm
CACB354602
20/
194.34
60 mm
CACB354601
20/
202.25
100 mm
CACB354600
10/
217.66
Multiwell Plates
6-Well Plate
CA-CB354432
2/
435.44
12-Well Plate
CA-CB354503
2/
447.23
24-Well Plate
CA-CB354433
2/
463.01
48-Well Plate
CA-CB354508
2/
472.86
Thin Layer Multiwell Plates
6-Well Plate
CA-CB354603
5/
207.92
24-Well Plate
CA-CB354605
5/
211.84
96-Well Plate
CA-CB354607
5/
237.35
Multiwell Plates for Hepatocytes
6-Well Plate
CACB354510
5/
478.41
BD Matrigel
™
Basement Membrane
Matrix, BD Biosciences
Trusted Provider of Reconstituted
Basement Membranes Since 1985
•
Provides the substrate necessary for the study of angiogenesis and the propagation
of human tumor cells
•
Certified LDEV-free
•
Growth factor reduced (GFR) is best for applications where a highly defined
basement membrane preparation is desired
•
High concentration (HC) is ideal for in vivo applications where high protein
concentration augments tumor growth
•
Phenol-red free (PRF) is recommended for assays that require color detection
•
hESC-qualified matrix has been qualified as mTeSR
™
-1 compatible and is an
effective feeder-free surface for human stem cell maintenance
Description
Size, mL
Cat. No.
Each
BD Matrigel Matrix
5
CACB356234
228.14
BD Matrigel Matrix
10
CACB354234
363.47
BD Matrigel Matrix
5 x 10
CACB-356235A
1527.31
GFR Matrix
5
CACB356230
256.49
GFR Matrix
10
CACB354230
404.60
GFR & HC Matrix
10
CABD354263
435.44
GFR & PRF Matrix
10
CACB356231
429.12
hESC-Qualified Matrix
5
CACB354237
214.23
HC Matrix
10
CACB354248
523.51
HC & PRF Matrix
10
CABD354262
435.44
PRF Matrix
10
CACB356237
410.32
Invasion Assays
bd matrigel matrix
provides a biologically
active basement mem-
brane model for in vitro
invasion assays. Image
shows a scanning elec-
tron micrograph of two
human fibrosarcoma
cells that have digested
the bd matrigel matrix
and are migrating
through the 8µm pore
of the PeT membrane.
Metabolism/
toxicology studies
bd matrigel matrix has
been used to success-
fully construct in vitro
models of liver cells for
drug toxicity studies.
note the typical appear-
ance of the clusters of
spherical hepatocytes
cultured on bd matrigel
matrix.
BD B
i
osc
i
ences
Cell Counting
microscopes
22
|
The
EssEntials
of
Tissue Culture
find Complete Product listings at
vwr.com
or Call
1.800.932.5000
|
23
Cell CultiVation
specialty surface flasks, Plates, dishes

Hts transwell
®
-24 Permeable
supports system, Corning
•
Provide an excellent substrate for adherent cell attachment, growth,
and differentiation
•
Tissue-culture treated membrane has a 6.5mm dia. and 0.4µm pore size
•
Open culture reservoirs provide a common outer well, making it easier
to change media while feeding cells
•
Individually wrapped supports also include two sterile, individually
wrapped open culture reservoirs
•
Sterilized by gamma radiation
Packaging
Cat. No.
Case of
Supports with Polycarbonate Membrane
Individually Wrapped
29445-098
2/
226.59
Bulk Packed
29445-100
12/
1253.87
Supports with Polyester Membrane
Individually Wrapped
46610-178
2/
232.97
Bulk Packed
66025-540
12/
1289.17
Accessories
Open Culture Reservoir
29445-096
48/
181.46
Hts transwell
®
96-Well Permeable
support systems and Plates, Corning
•
Ideal for ADMET screening, drug transport, and other assays
•
Large apical and basolateral access ports allow efficient media sampling and
facilitate automated or manual access
•
The reservoir plate allows for simultaneous feeding of 96 wells and is supplied
with a removable media stabilizer to reduce the risk of spills
•
Complete systems come with the 96-well plate packaged with a single-well
reservoir plate, a 96-well receiver plate, and two lids
•
Support plates only come with the 96-well insert plate, a 96-well receiver plate,
and one lid
•
Sterilized by gamma radiation
Membrane Pore
Size, µm
Membrane
Material
Cat. No.
Case of
Support Systems
0.4
PC
89089-924
5/
1529.54
1
PET
89089-928
5/
1529.54
Support Plates
3
PC
89089-932
8/
734.17
5
PC
89089-936
8/
734.17
8
PET
89089-938
2/
179.92
Accessories
Receiver Plate with Lid
—
89089-944
10/
165.21
Reservoir Plate with Lid
—
89089-946
10/
118.98
transwell Dish inserts, Corning
•
Polycarbonate inserts are for use in epithelial and endothelial cell culture,
transport, migration/invasion, co-culture, and microbial pathogenesis studies
•
Provide independent access to both the apical and basolateral sides of
the cell monolayer
•
Diameter.. 75mm (3"); well area.. 44cm
2
•
Sterile
Pore Size, μm
Cat. No.
Case of 12
0.4
29442-114
416.64
3.0
29442-116
416.66
snapwell
™
inserts, Corning
•
Tissue-culture treated inserts are designed for use with diffusion chambers
•
Polycarbonate membrane is supported by a detachable ring and is housed
in a two-piece polystyrene assembly
•
Supplied preloaded into 6-well plates
Density, cm
2
Pore Size, μm
Cat. No.
Case of 24
108
0.4
29442-160
197.80
find Complete Product listings at
vwr.com
or Call
1.800.932.5000
|
23
Cell CultiVation
membrane Inserts

transwell
®
Plate inserts, Corning
•
Designed for use in epithelial and endothelial cell culture applications
•
Provide independent access to both apical and basolateral plasma membranes
•
Microporous membrane inserts are available in polyester, polycarbonate, and PTFE collagen formats
•
Once stained, they allow excellent cell visibility with phase contrast microscopy
•
Supplied preloaded into multiwell plates
No. of Wells
Well Area, cm
2
Insert Size, mm
Pore Size, µm
Cat. No.
Case of
Polyester Tissue Culture-Treated Inserts
6
4.7
24
0.4
29442-074
24/
135.41
6
4.7
24
3
29442-076
24/
135.41
12
1
12
0.4
29442-078
48/
244.77
12
1
12
3
29442-080
48/
244.78
24
0.3
6.5
0.4
29442-082
48/
229.16
24
0.3
6.5
3
29442-084
48/
229.16
Polycarbonate Tissue Culture-Treated Inserts
6
4.5
24
0.4
29442-104
24/
132.83
6
4.5
24
3
29442-108
24/
135.41
6
4.5
24
8
29442-130
24/
135.41
12
1.1
12
0.4
29442-086
48/
247.39
12
1.1
12
3
29442-088
48/
247.39
24
0.3
6.5
0.4
29442-106
48/
229.16
24
0.3
6.5
3
29442-110
48/
229.16
24
0.3
6.5
5
29442-118
48/
229.16
24
0.3
6.5
8
29442-120
48/
229.16
Polytetrafluoroethylene Collagen-Coated Inserts
6
4.7
24
0.4
29442-125
24/
330.36
12
1
12
0.4
29442-092
24/
302.29
24
0.3
6.5
0.4
29442-129
24/
287.35
Roller Bottles, Corning
•
Treated for optimal cell attachment
•
850cm
2
bottles feature printed graduations
•
1750cm
2
bottles feature molded-in graduations
•
Supplied with high-density easy grip caps
•
Sterilized by gamma radiation; certified nonpyrogenic
Expanded surface Roller
Bottles, Corning
•
Ribbed design provides twice the surface area of
traditional 850cm
2
bottles
•
Two lengthwise windows provide a clear view for
microscopy and facilitate drainage
•
Bottles are treated for optimal cell attachment
•
Supplied with high-density easy grip caps
•
Sterilized by gamma radiation; certified nonpyrogenic
Packaging
Cat. No.
Case of 40
2 Bottles/Bag
62404-446
532.87
Culture Area,
cm
2
Cap Type
Packaging
Cat. No.
Case of
490
Plug Seal
2 Bottles/Sleeve
62404-370
40/
255.61
850
Easy Grip
2 Bottles/Sleeve
62404-442
40
/312.68
850
Easy Grip
5 Bottles/Sleeve
62404-444
40
/325.07
850
Easy Grip
Bulk Pack
21008-660
20/
154.03
850
Easy Grip, Vent
2 Bottles/Sleeve
25382-462
40
/375.23
1750
Easy Grip
10 Bottles/Sleeve
62404-440
20/
408.33
do you need a CustoMized Media
PreParation solution?
for a number of years,
vWr
CaTalysT team members have been performing various types of
media prep and sample testing. Today, we have the people, processes, and technology to offer
a customized solution for virtually any media prep or sampling problem. Call
1.888.793.2300
or
visit
ca.vwr.com/vwrcatalyst
for more information.
find Complete Product listings at
vwr.com
or Call
1.800.932.5000
|
24
24
|
The
EssEntials
of
Tissue Culture
find Complete Product listings at
vwr.com
or Call
1.800.932.5000
|
25
Cell CultiVation
membrane Inserts | roller bottles

CellstaCK
®
Culture Chambers, Corning
•
Feature USP Class VI polystyrene construction for excellent optical clarity and
mechanical strength
•
Two 26mm dia. filling ports allow direct access to the chamber bottom, for greater
flexibility in filling and emptying by pouring, pipetting, or tubing
•
Self-venting 33mm threaded caps feature 0.2µm pore membranes sealed directly to
the caps for efficient gas exchange without the risk of contamination
Growth Area, cm
2
No. of Chambers
Cat. No.
Case of
Standard CellSTACK Culture Chambers
636
1
33500-818
8/
389.57
1272
2
33500-820
5/
297.75
3180
5
66025-656
2/
280.93
3180
5
22250-152
8/
1070.75
6360
10
33500-822
2/
422.48
6360
10
33500-824
8/
1242.60
25440
40
16001-330
2/
1637.84
CellSTACK Culture Chambers with CellBIND
®
Surface
636
1
66025-624
8/
557.30
1272
2
66025-618
5/
425.92
3180
5
66025-628
2/
558.31
6360
10
89178-350
2/
820.04
6360
10
66025-620
6/
2484.04
25440
40
66025-622
2/
2931.20
CellSTACK Culture Chambers with Ultra-Low Attachment Surface
636
1
89089-960
8/
1301.59
HYPERFlask
®
Cell Culture
Vessels, Corning
•
High-yield flasks utilize a multilayered, gas-permeable
growing surface for efficient gas exchange
•
10X higher yields increase productivity and reduce
processing time
•
Ten interconnected polystyrene surfaces provide 1720cm
2
growth area with an air gap between each layer
•
CellBIND
®
surface treatment is on every gas permeable
layer to improve cell attachment and growth
•
Feature straight neck, flat-top cap, and bar code
•
HYPERFlask M vessels are designed for manual use and
feature an ergonomic cap
•
Sterilized with gamma irradiation; certified nonpyrogenic
CellBinD
®
Roller
Bottles, Corning
•
Surface treatment improves cell
attachment by incorporating more
oxygen into the cell culture surface
•
CellBIND surfaces are nonbiological and
require no special handling or storage
•
One-piece seamless construction features
a wide mouth and printed graduations
•
Polystyrene bottles come with high-
density polyethylene caps
•
Provide 850cm
2
of culture area
•
Sterilized by gamma radiation;
certified nonpyrogenic
CEllMastER
™
Roller Bottles,
Greiner Bio-One
•
Polystyrene bottles offer stability and optical
clarity and feature treated surfaces for improved cell adhesion
•
Polyethylene terephthalate (PET) bottles provide increased
flexibility, sturdiness, and resistance to cracking for use in
either automatic or manual procedures
•
Two-phase blow-molding procedure creates seamless construction
•
Features lot number and best before dates on the label
•
Standard seal cap sits flush with rim of bottle to prevent significant gas exchange
•
Vented filter cap guarantees tightly closed, contamination-free cultivation
•
Single use bottles offer 850cm
2
culture area
•
Sterilized by gamma irradiation; noncytotoxic and nonpyrogenic
•
USP Class VI certified; DNase-, RNase-, and human-DNA free
Bottle Material
Packaging
Cat. No.
Case of
Standard Seal Cap
PET
30 Bottles/Bag
89049-110
30/
159.04
Polystyrene
2 Bottles/Bag
82051-012
24/
123.50
Polystyrene
24 Bottles/Bag
82051-008
48/
247.00
Vented Filter Cap
Polystyrene
2 Bottles/Bag
82051-010
24/
142.98
Polystyrene
24 Bottles/Bag
82051-006
48/
286.39
Packaging
Cat. No.
Case of
2 Bottles/Bag
33500-694
40/
931.58
22 Bottles/Bag
89089-838
44/
661.60
Packaging
Cat. No.
Case of
HYPERFlask Vessels
Double Bagged
89089-848
24/
2400.97
HYPERFlask M Vessels
Individually Wrapped
89125-584
4/
456.00
Double Bagged
89125-582
4/
456.00
Double Bagged
89125-586
24/
2735.99
find Complete Product listings at
vwr.com
or Call
1.800.932.5000
|
24
find Complete Product listings at
vwr.com
or Call
1.800.932.5000
|
25
Cell CultiVation
roller bottles | Chambers & systems

growing More Cells:
a simple guide to small Volume Cell Culture scale-up
Introduction
We need more cells… Researchers are constantly
being challenged to produce more cells for cell-based
experiments and assays, or for producing recombinant
proteins, antibodies and viral vectors. Researchers must
choose from a sometimes confusing variety of cell cul-
ture vessels, systems and methods to meet their needs for
larger quantities of cells. This Corning guide is designed
to help researchers select the vessels and methods that
can best meet all of their needs for growing more cells
or producing more cell products. It will focus on basic
systems suitable for producing at least 1 x 10
9
cells
(approximately one gram).
Selecting the Best System
The key to selecting the best system for your needs is to
thoroughly understand and evaluate these five key areas:
Attachment requirements
•
Cell or product yields desired
•
Equipment and space requirements
•
Labor requirements and availability
•
Investment in technology and expertise to operate
(ease of use)
Once each of these four areas have been thoroughly
evaluated and understood, selecting the system that best
meets your needs will be much easier.
Matching the Culture System with the
Attachment Requirements of the Cells
The first and most important step is to determine the
attachment requirements of your cells.
Some cell lines are attachment-dependent, that is, they
can only grow when attached to a suitable substrate
such as a flask or roller bottle. Many other cell lines,
frequently designated as transformed cell lines, are able
to grow either attached to a substrate or floating unat-
tached in suspension; they are attachment-independent.
In general, if the cells allow it, it is always easier to grow
large amounts of animal cells in suspension culture than
in attached culture. Some cell lines used to produce
genetically engineered proteins will also have higher
yields when grown in suspension culture. If cells are
attachment-dependent, it may be possible to adapt them
to grow in suspension. However, even if the cells can be
adapted to grow in suspension, they may not maintain
the same characteristics or produce the same amount of
products that they did when grown attached (Iyer et al.;
1999). It may also be necessary to screen the cultures
after adaptation to select for high producers or the
desired cell characteristics.
For short term projects, it may not be worth the effort
to attempt to adapt attachment dependent cells to grow
in suspension. For longer term or ongoing projects, it is
usually worth the effort to attempt to adapt cultures to
grow in suspension.
Advantages of growing cells in
attached culture systems:
•
Easier to feed but harder to subculture
•
Easier to view cultures to check status
•
Avoids physical stresses on cells caused by stirring or
shaking which may lead to higher yields
Advantages of growing cells in
suspension culture systems:
•
Easier to sample but harder to feed
•
Most economical for large amounts of cells
•
Less labor intensive
•
May provide better gas exchange than static
monolayer systems
•
Less space needed because cells grow in three
dimensions versus two in monolayer culture
Another alternative for growing attachment-dependent
cells in suspension is to use microcarriers in modified
spinner flasks (Figure 1). Microcarriers are small (100
to 300μm) sterile glass or polymeric beads to which
the cells attach and grow while the beads are kept in
suspension by the rotation of the paddle. Microcarriers
do not work well with all cell types and have their own
unique problems and requirements. They are beyond
the scope of this guide; please refer to references
(McLimans; 1979, Freshney; 2000) for information on
using microcarriers.
John a. ryan, Ph.d., Corning Incorporated
figure 1: attachment-
dependent cells
can also be grown
in spinner flasks on
microcarrier beads.
The following is an
excerpt from the more
detailed document of
the same name found
on the vwr.com litera-
ture page.
LIFE SCIENCE RESEARCHERS ARE CoNSTANTLY
BEING CHALLENGED To PRoDuCE MoRE CELLS
find Complete Product listings at
vwr.com
or Call
1.800.932.5000
|
26
26
|
The
EssEntials
of
Tissue Culture
find Complete Product listings at
vwr.com
or Call
1.800.932.5000
|
27
Cell CultiVation
Chambers & systems

Most often, cells are seeded in a 1-chamber or 2-chamber Cell Factory as a control.
Cells grown in these smaller Cell Factories can be viewed under a microscope.
For larger Cell Factories, the first few layers can be viewed using inverted stereo
microscopes with a powerful light source on the view side that has been adjusted
to the height of the Cell Factory.
F cus
nformation
nunclon
®
Δ Cell Factories, thermo scientific
•
Maximize growing area while reducing the risk of contamination
•
Feature a common vent and fill ports
•
Openings connecting the chambers cause media to fill evenly for consistent growth condition
•
Starter kit includes an HDPE connector, Tyvek
®
cell factory caps, sealing caps, tubing, clamp, and
bacterial air vent
Growth Area, cm
2
No. of Chambers
Cat. No.
Case of
632
1
CA62407-098
8/
468.63
1264
2
CA62407-099
5/
362.03
6320
10
CA62407-100
2/
490.92
6320
10
CA62407-106
6/
1366.67
VWR
®
Disposable serological Pipets, Glass
•
Feature a uniform pulled tip and negative graduations
•
Calibrated to deliver to the tip
•
Manufactured from borosilicate glass in compliance with ASTM Specification E438,
Type I, Class B requirements
•
Bulk pack pipets are sealed in plastic bags and overpacked in dispensing packs
•
Individually wrapped pipets are plugged, sterile, packaged in color-coded wraps, and
overpacked in dispening packs for laboratory benches
•
Multi-pack pipets are plugged and sterile and come in color-coded bags of 25 pipets
(1mL and 2mL sizes) or 10 pipets (5mL and 10mL sizes)
Capacity,
mL
Graduations,
mL
Subdivisions,
mL
Tolerance,
± mL
Cat. No.
Case of
Bulk Pack Pipets
1
0.2
0.01
0.02
93000-702
1000/
198.52
2
0.2
0.01
0.04
93000-742
500/
111.69
5
1
0.1
0.15
93000-704
500/
167.91
10
2
0.1
0.30
93000-706
500/
184.61
Individually Wrapped Pipets
1
0.2
0.01
0.02
93000-692
1000/
248.07
2
0.2
0.01
0.04
93000-694
500/
145.03
5
1
0.1
0.15
93000-696
500/
199.06
10
2
0.1
0.30
93000-698
500/
212.27
Multi-Pack Pipets
1
0.2
0.1
0.02
93000-672
1000/
166.01
2
0.2
0.01
0.04
93000-676
500/
99.41
5
1
0.1
0.15
93000-678
500/
131.08
10
2
0.1
0.30
93000-680
500/
150.43
did you know
that Vwr also offers a
pipet controller? Contact your Vwr sales
representative for more information.
find Complete Product listings at
vwr.com
or Call
1.800.932.5000
|
26
find Complete Product listings at
vwr.com
or Call
1.800.932.5000
|
27
Cell CultiVation
Chambers & systems | Pipetting

pipetus
®
Pipetting Device, Hirschmann
•
Fast, safe, and precise, with five speeds to match your ideal
pipetting rate
•
Ergonomic, lightweight (240g) pipettor has color LCD panel
•
Performs up to 50 hours before batteries need to be recharged
•
Pump aspirates 50mL in less than seven seconds
•
Rechargeable cadmium-free nickel-metal hydride (NiMH)
batteries are included
•
CE marked
Volume Range
Cat. No.
Each
0.1–200 mL
83007-692
314.84
VWR
®
Disposable serological Pipets, Polystyrene
•
For sterile serological and tissue culture applications
•
Calibrated to deliver
•
Feature black ascending and descending negative graduations
•
Accuracy is at ±2% at full volume
•
All plastic polyethylene packaged pipets allow for aseptic removal
•
Paper/plastic packaging is designed to reduce static cling
•
Choose bulk packaging for high volume liquid handling applications
Capacity, mL
Subdivisions, mL
Color Code
Cat. No.
Case of
Individually Wrapped in All-Plastic Polyethylene
1
0.01
Yellow
89130-882
1000/
171.42
2
0.01
Green
89130-884
1000/
222.01
5
0.1
Blue
89130-886
200/
62.41
10
0.1
Orange
89130-888
200/
62.67
25
0.2
Red
89130-890
200/
154.34
Individually Wrapped in Paper/Plastic
1
0.01
Yellow
89130-892
1000/
163.84
2
0.01
Green
89130-894
500/
103.66
5
0.1
Blue
89130-896
200/
55.90
10
0.1
Orange
89130-898
200/
60.42
25
0.25
Red
89130-900
200/
131.09
50
1
Purple
89130-902
100/
142.69
Bulk Packed in Resealable Polyethylene Bags of 50
1
0.01
Yellow
89130-904
1000/
155.77
2
0.01
Green
89130-906
500/
101.10
5
0.1
Blue
89130-908
500/
123.18
10
0.1
Orange
89130-910
500/
141.61
10 (Wide Tip)
0.1
Orange
89130-916
500/
164.46
Bulk Packed in Resealable Polyethylene Bags of 25
25 (Wide Tip)
0.25
Red
89130-912
200/
131.20
Bulk Packed in Resealable Polyethylene Bags of 20
50
0.5
Purple
89130-914
100/
147.39
Conical silicone adapter
provides secure fit on
all pipets
Volume Range: 0.1-200mL
Touch-sensitive
buttons precisely
control meniscus
adjustment
Inductive charging stand keeps
batteries fully powered
find Complete Product listings at
vwr.com
or Call
1.800.932.5000
|
28
28
|
The
EssEntials
of
Tissue Culture
find Complete Product listings at
vwr.com
or Call
1.800.932.5000
|
29
Cell CultiVation
Pipetting

A Convenient Way to Teach Ergonomics
in the Lab and Reduce Injuries
Pipetting is heavy work. No less than 44% of
lab professionals suffer from injuries caused by
prolonged overuse, pressure, force, or awkward and
static postures associated with pipetting.
Over 300 hours of pipetting per year (1.5 hours per
day) causes exposure to Repetitive Strain Injury
(RSI), a soft tissue disorder affecting muscles, ten-
dons, ligaments, and nerves.
The Biohit Pipetting Academy is your resource for
better safety in the lab. The academy offers onsite
training as well as a website featuring videos that
will guide you through the essentials of laboratory
ergonomics.
VWR
®
Ultra High-Performance Pipettors
•
Soft-plunger system ensures light aspiration and dispensing forces
•
Levered ejection mechanism is designed to provide smooth and
gentle tip ejection
•
Volume adjustment wheel can be locked to prevent accidental
volume changes
•
Four-digit micrometer allows for fine control over volume
adjustment
•
Multi-channel pipettors include a self calibration tool for in lab
calibration when used with a balance
Volume Range, µL
Accuracy, %
Precision, %
Cat. No.
Each
Single-Channel Pipettors
0.1–2.0
±12.0–1.5
≤6.0–0.7
89130-552
350.87
0.5–10
±4.0–0.5
≤2.8–0.4
89130-554
350.87
2–20
±3.0–0.8
≤1.5–0.3
89130-556
271.93
5–50
±3.0–0.8
≤2.0–0.4
89130-558
271.93
10–100
±1.6–0.8
≤0.8–0.2
89130-560
271.93
20–200
±1.2–0.6
≤0.6–0.2
89130-562
271.93
100–1000
±0.9–0.6
≤0.4–0.15
89130-566
271.93
8-Channel Pipettors
1–10
±8.0–2.0
≤6.0–1.2
89134-744
584.54
5–50
±4.0–1.6
≤2.8–0.6
89134-746
584.54
20–200
±3.0–1.0
≤1.5–0.6
89134-748
584.54
50–300
±1.6–1.0
≤1.5–0.6
89134-750
584.54
12-Channel Pipettors
1–10
±8.0–2.0
≤6.0–1.2
89134-752
703.93
5–50
±4.0–1.6
≤2.8–0.6
89134-754
703.93
20–200
±3.0–1.0
≤1.5–0.6
89134-756
703.93
50–300
±1.6–1.0
≤1.5–0.6
89134-758
703.93
find Complete Product listings at
vwr.com
or Call
1.800.932.5000
|
28
find Complete Product listings at
vwr.com
or Call
1.800.932.5000
|
29
Cell CultiVation
Pipetting

Robotic tips, Biotix
•
Manufactured to the highest engineering standards for robotic systems
•
Standard tip definitions bundled in the robotic software program allows
problem-free use
•
Delta Filter
™
changes color when contacted by liquids or aerosols
•
All tips are packed with 384 tips/rack; 10 racks/pack; 5 packs/case
•
Sterile
Description
Volume,
µL
Tip Length,
mm
Cat. No.
Case of 5
Standard Robotic Tips
Agilent
™
Velocity 11
®
VPrep
®
/Bravo
Robotic Tip
30
25.83
89129-582
2913.42
Beckman
®
Biomek
®
AP384 P30
Robotic Tip
30
33.15
89108-096
2340.25
Robotic Tips with Delta Filter
Beckman
®
Biomek
®
AP384 P30
Robotic Tip
30
33.15
89129-576
3652.13
Beckman
®
Biomek
®
AP384 P30
Robotic Tip
50
43.15
89129-578
2978.14
axygen now Has QiaGEn
®
Biorobot
Qiagility
™
and OnCor tips!
Axygen provides a comprehensive line of robotic tips for Qiagen
automation systems. Our in-house engineering/tooling department has
tremendous expertise in designing/creating molds that produce consis-
tent, high-quality products. Our automated production process and our
experienced personnel ensure all products are free from contamination.
NeW!
Tips are also available for the following automation platforms:
•
BECKMAN COULTER
®
•
Biomek
®
FX, Biomek
®
NX and Multimek
™
•
Biomek
®
3000
•
Biomek
®
NX with SPAN-8 liquid level sensing head
•
Biomek
®
1000 & Biomek
®
2000
•
SAGIAN Multipette
•
AGILENT / VELOCITY 11
®
VPrep
®
and Bravo
•
TECAN
®
•
Genesis Freedom
®
, Freedom Evo
®
and Miniprep with LiHa
•
TeMo & Aquarius
•
CORBETT CAS-1200
™
with LLT and X-tractor Gene
•
PERKINELMER
®
•
Janus
®
, Evolution P3, MiniTrak and PlateTrak
®
•
Janus
®
MultiProbe
•
CORBETT CAS-4200
™
•
ZYMARK
®
/CALIPER
•
RapidPlate
®
, SciClone
®
and Zephyr
®
•
BIOTEK
®
Precision
™
and Precision
™
xs
•
AURORA BIOMED Versa
®
•
DYNAMIC DEVICES Oasis LM
•
HAMILTON
®
Microlab
®
STAR, STARlet and STARplus
•
WELLPRO
VWR
®
signature
™
Zapslik low
adhesion Filter Pipet tips
•
Modified polypropylene surface limits the adhesion of cells, rDNA, and other
viscous materials
•
Filter is made of a polyethylene that does not have any cellulose gum or toluene to
contaminate samples
•
Pore size is 10µm to block even the smallest radionucleotides
•
Certified free of DNase, RNase, protease, and human DNA; certified non-pyrogenic
•
Sterile; autoclavable
Size, µL
Packaging
Cat. No.
Case of
10 Packs
Standard Length Tips
10
96 Tips/Rack, 12 Racks/Pack, 10 Packs/Case
89174-520
930.77
20
96 Tips/Rack, 10 Racks/Pack, 10 Packs/Case
89174-524
930.77
200
96 Tips/Rack, 10 Racks/Pack, 10 Packs/Case
89174-526
930.77
300
96 Tips/Rack, 10 Racks/Pack, 10 Packs/Case
89174-528
930.77
1000
96 Tips/Rack, 6 Racks/Pack, 10 Packs/Case
89174-530
421.45
Extended Length Tips
10
96 Tips/Rack, 12 Racks/Pack, 10 Packs/Case
89174-522
744.62
find Complete Product listings at
vwr.com
or Call
1.800.932.5000
|
30
30
|
The
EssEntials
of
Tissue Culture
find Complete Product listings at
vwr.com
or Call
1.800.932.5000
|
31
Cell CultiVation
Pipetting

VWR
®
symphony
™
incubating Orbital shaker
•
Variable speed microprocessor control provides consistent and uniform mixing
action with the ability to restart and display last set-point
•
Precise temperature control is maintained by a PID controller
•
Accu-drive
™
shaking system continuously monitors shaking speed, even under
changing loads and will automatically reduce rpm during unbalanced conditions
•
Audible and visual signals will activate if the system detects a tray obstruction
or overload
•
Polycarbonate lid allows viewing of samples without disturbing internal
temperatures and an automatic shutoff circuit will stop the platform movement
when the lid is opened
•
A caution symbol will illuminate when the air temperature inside the shaker
reaches 40°C (104°F) and will remain lit until the chamber cools
•
Refrigeration model will cool the air inside the unit down to -15°C (5°F)
•
Electrical
..
120V, 50
/60 Hz
•
Five year warranty on drive system and motor
Description
Cat. No.
Each
Model 5000I Incubating Orbital Shaker
97009-890
8267.97
Model 5000I/R Incubating/Refrigerating Orbital Shaker
97009-894
10,343.52
VWR
®
incubating Orbital shaker
•
Features variable speed microprocessor control for consistent, uniform
mixing action
•
Easy-to-use, spill-resistant touchpad controls adjust temperature in 1°C
increments
•
Opti-flow forced ventilation system uses twin induction fans and air
deflectors to deliver exceptional temperature uniformity and stability
•
Accu-drive
™
shaking system continuously monitors shaking speed, even
under changing loads and will automatically reduce rpm during unbalanced
conditions
•
Triple eccentric drive with brushless motor is designed for continuous duty
and heavy loads
•
RS-232 serial port provides two-way communication for data logging and
unit control
•
Electrical
..
120V, 50
/60 Hz
•
CSA certified and CE marked
•
Five year warranty on drive system and motor
Description
Cat. No.
Each
Incubating Orbital Shaker
12620-946
4270.46
C series air-Jacketed CO
2
incubators, Binder
•
Overnight hot air sterilization cycle operates at 180°C (356°F)
•
Weldless, deep-drawn inner chamber features an integrated shelf support
system with three perforated, stainless steel shelves
•
Tightly closing inner glass door and seamless, jointless design prevent the
accumulation of particulate matter
•
Features a drift-free IR sensor for absolute CO
2
management
•
Safety features include an automatic diagnostic system and zero-potential
alarm contact
•
Incubator door is lockable and available with a right- or left-hinge opening
•
Available stand-alone or stacked
•
UL listed
•
Electrical
..
115V, 50
/60Hz, 1200W
Description
Cat. No.
Each
Stand-Alone Single Incubator
Right-Hinged Door
97000-602
8508.00
Left-Hinged Door
97000-604
8508.00
Stacked Single Incubator
Right-Hinged Door
97000-610
16,776.00
Left-Hinged Door
97000-612
16,776.00
CB150 air-Jacketed CO
2
incubators, Binder
•
Features the APT.Line
™
air jacket system for temperature accuracy and
reproducible results
•
Permadry
™
system keeps chamber walls and door dry at a maximum
humidity of 98%
•
Overnight hot air sterilization cycle operates at 180°C (356°F)
•
Seamless, jointless design prevents the accumulation of particulate matter
•
Optional intelligent fail-safe function ensures continuous monitoring of the
CO
2
concentration
•
Vibration-free stacking frames are designed on castors with stop brake and
wedge equipment
•
UL listed
•
Electrical
..
115V, 50
/60Hz, 1400W
Description
Cat. No.
Each
Stainless Steel Interior
CA80200-008
11,586.16
Divided Door
CA80200-024
12,236.57
O
2
Control
CA80200-016
15,449.00
O
2
Control and Divided Door
CA80200-032
16,215.82
find Complete Product listings at
vwr.com
or Call
1.800.932.5000
|
30
find Complete Product listings at
vwr.com
or Call
1.800.932.5000
|
31
Cell CultiVation
shakers | Incubators

VWR
®
symphony
™
Water-Jacketed CO
2
incubators
•
Cultures are protected by a non-corrosive stainless steel chamber, insulated triple-wall cabinet construction, and a jacket of
temperature-conditioned water
•
Internal shelves and supports are easily installed and removed
•
Guarantees protection from unwanted heat loss, even in the event of a power outage
•
Creates cleanroom Class 100 conditions, preserving the aseptic culturing environment
•
Available with thermal conductivity (TC) or infrared (IR) sensor-based CO
2
control
Sensor
Cat. No.
Each
Single-Unit Incubator
TC
CA89050-212
7123.54
IR
CA89050-214
8548.25
TC with HEPA Filter
97025-836
7789.81
IR with HEPA Filter
97025-838
9140.13
Dual-Stacked Incubator
TC
CA89050-206
14,247.07
IR
CA89050-208
17,196.67
TC with HEPA Filter
97025-840
15,568.19
IR with HEPA Filter
97025-842
16,990.86
GelJacket
™
Benchtop CO
2
incubator, Caron
•
Will sustain temperature after door openings and during power outages longer than any incubator on the market
•
Compartmentalized gel is lightweight and features a volumetric heat capacity 40X greater than water
•
CO
2
is quickly recovered and is accurately controlled by an IR sensor
•
gVapor
™
sensor delivers precise, controlled humidity on an as needed basis
•
Automatic decon cycle rapidly cleans the unit overnight
•
The refrigerated model will accommodate heat-generating equipment, such as shakers and stirrers
Description
Cat. No.
Each
GelJacket Incubator
89173-386
16,794.00
Refrigerated GelJacket Incubator
89173-392
19,194.00
Oasis
™
Benchtop iR CO
2
incubator, Caron
•
Tri-zone temperature control utilizes individual heaters located on the outside of every interior wall to ensure
highly uniform and rapidly recovering temperature
•
CO
2
is recovered quickly after door openings and is accurately controlled by an infrared (IR) sensor
•
Stainless steel interior with coved corners and ISOCIDE antimicrobial powder coated exterior work together to
prevent contamination
•
Maintenance-free decon cycle rapidly cleans the unit overnight with the push of a button
Description
Cat. No.
Each
Oasis CO
2
Incubator
97052-136
8698.09
F cus
nformation
F cus
nformation
Caron’s oasis Benchtop Co
2
Incubator incorporates innovative
and proven technologies to bring you an ultra stable, stackable
incubator designed for cell and tissue cultures. The new Co
2
incubator is 6 cu. ft. and features a high grade, stainless steel
interior. Numerous optional accessories are available to
customize this incubator to your application. Contact your
VWR Sales Representative for more informaton.
Caron’s 10 cu. ft. GelJacket Benchtop Co
2
Incubator is the most innovative technological
advancement for cell culture incubators in decades. GelJacket has high-energy thermal
absorbing gel located in every incubator wall. This design has advantages far surpassing
any other Co
2
incubator.
find Complete Product listings at
vwr.com
or Call
1.800.932.5000
|
32
32
|
The
EssEntials
of
Tissue Culture
find Complete Product listings at
vwr.com
or Call
1.800.932.5000
|
33
Cell CultiVation
Incubators

VWR
®
symphony
™
air-Jacketed
CO
2
incubator, Model 1.4a
•
Excellent for space-constrained working environments
•
Radiant wall heating provides accurate, uniform temperatures and
optimal recovery
•
Simple, three-button touchpad allows quick access to all functions
•
High-visibility digital readouts simplify operation and monitoring
•
Seamless stainless steel interior chamber features coved corners,
making it easy-to-clean
•
Unit uses a microprocessor-based, automatic thermal conductivity
(TC) CO
2
control
Description
Cat. No.
Each
Model 1.4A CO
2
Incubator
CA89050-210
3001.00
VWR
®
symphony
™
air-Jacketed CO
2
incubators
•
Advanced, air-jacketed temperature control technology ensures an
optimal and stable growing environment
•
Unique panless humidity water reservoir protects cultures from
drying out, improving recovery characteristics and cell growth
•
Internal shelves and supports are easily installed and removed
without tools
•
Easy-to-use interface panel features separate large LED displays
for temperature and CO
2
parameters
•
Touch-sensitive membrane controls provide the status of
incubator functions
•
Convenient, dual-stacked configurations are available on some models
•
Units use thermal conductivity (TC) sensor-based CO
2
control
•
The moist heat, high temperature decontamination cycles offer total
decontamination without removing the sensors, fittings, or shelves
Description
Cat. No.
Each
Model 5.3A
Single-Unit Incubator
CA89050-218
6066.14
Single-Unit Incubator with High-
Temperature Decontamination
CA89050-216
6522.49
Dual-Stacked Incubator
CA89050-234
12,121.15
Dual-Stacked Incubator with High-
Temperature Decontamination
CA89050-232
12,788.98
Model 8.5A
Single-Unit Incubator
CA89050-226
9705.82
Single-Unit Incubator with High-
Temperature Decontamination
CA89050-224
10,785.48
Purifier
®
logic
®
Class ii Biosafety
Cabinets, labconco
®
•
Electronically commuted motor (ECM) consumes 60%
less energy and provides more power with cooler and
quieter operation
•
Constant Airflow Profile technology precisely controls
airflow without the need for sensors
•
LCD information center with touchpad control keeps
users aware of current cabinet conditions, while
allowing manual use of the menu
•
Touchpad control permits manual activation of blower,
light, timer, audible alarm mute, and menu selection
•
The Smart-Start
™
system allows the user to program
start up/shut down operations
•
Night-Smart
™
system idles the blower at 30% when
the sash is closed to help maintain a clean, particulate-
free environment
•
Supply and exhaust HEPA filters are 99.99% efficient
Sash Opening, cm (in.)
Service Fixture(s)
Exhaust Volume, cfm
Cat. No.
Each
Type A2 Models with 0.9 m (3’) Nominal Width
20.3 (8)*
1
203–223
97000-852
10,158.00
25.4 (10)*
1
253–279
97000-860
10,158.00
Type A2 Models with 1.2 m (4’) Nominal Width
20.3 (8)*
1
269–296
97000-854
11,472.00
25.4 (10)*
1
339–370
97000-862
11,472.00
Type A2 Models with 1.5 m (5’) Nominal Width
20.3 (8)*
1
336–370
97000-856
13,260.00
25.4 (10)*
1
420–462
97000-864
13,260.00
Type A2 Models with 1.8 m (6’) Nominal Width
20.3 (8)*
2
403–443
97000-858
14,520.00
25.4 (10)*
2
503–554
97000-866
14,520.00
Type B2 Models with 1.2 m (4’) Nominal Width
20.3 (8)
1
743–771
97000-834
14,882.43
Type B2 Models with 1.8 m (6’) Nominal Width
20.3 (8)
2
1111–1151
97000-838
17,328.78
*REDISHIP.
accessories for Purifier
®
HEPa-Filtered Enclosures, labconco
®
Description
Exterior Dimensions,
W x D x H, cm (in.)
Cat. No.
Each
Telescoping Base Stand with Casters
for 0.9 m (3’) Models
91.4 x 73.7 x 69.9–85.1
(36 x 29 x 27
1
/
2
–33
1
/
2
)
82003-570
968.71
Telescoping Base Stand with Casters
for 1.2 m (4’) Models
121.9 x 73.7 x 69.9–85.1
(48 x 29 x 27
1
/
2
–33
1
/
2
)
82003-572
1009.81
Solid Epoxy Dished Work Surface for
0.9 m (3’) Models
91.4 x 73.7 x 2.5
(36 x 29 x 1)
82018-190
688.20
Solid Epoxy Dished Work Surface for
1.2 m (4’) Models
121.9 x 73.7 x 2.5 (48 x 29 x 1)
82018-192
849.50
Purifier
®
Vertical Clean Benches, labconco
®
•
Ideal for applications requiring a particulate-free work area
•
Variable speed blowers feature solid-state speed to maintain
proper air velocities
•
The HEPA filter removes 99.99% of all particulates greater
than 0.3μm
•
An aerodynamic airfoil allows filtered air to sweep the work surface,
promoting ISO Class 5 (FED-STD-209E Class 100/M3.5) conditions
Description
Cat. No.
Etach
Vertical Clean Bench
89000-138
6120.00
find Complete Product listings at
vwr.com
or Call
1.800.932.5000
|
32
find Complete Product listings at
vwr.com
or Call
1.800.932.5000
|
33
Cell CultiVation
Incubators | biosafety Cabinets

enclosures and biosafety Cabinets
The majority of steps conducted in tissue culture are
done inside an enclosure that provides HEPA-filtered air
(a sterile work area), to prevent contamination of the
cell lines.
The types of cells you are working with will determine
the appropriate enclosure and level of protection needed
for culturing techniques. Cells, such as plant tissue and
non-hazardous mammalian cells, may be handled in a
still air enclosure. This non-ventilated enclosure provides
a quiet work area with relatively little air movement
for minimal disruption and contamination. Additional
protection from contamination is achieved by using
a horizontal or vertical clean bench. These enclosures
bathe the work area in HEPA-filtered sterile air, but
provide no protection to the researcher.
When working with bacteria, viruses, and potentially
harmful mammalian cell lines, a Class II biological safety
cabinet provides protection for the product, as well
as the worker and the lab environment. Class II, Type
A2 cabinets provide HEPA-filtered vertical airflow to
provide a sterile work environment. In addition, they
capture and filter the air, recirculate some air within the
cabinet, and exhaust the remainder to the room. The
Class II cabinet may be preferred when preparing dry
powder media, since it captures the particulates in the
air stream without introducing them into the room. The
Class II biological safety cabinet may be exhausted to
the outside using a canopy connection. This will prevent
build-up of odors inside the cabinet and the laboratory.
Work that includes the use of volatile solvents, radio-
nucleotides, or other hazardous gaseous chemical agents
requires a Class II Type B2 "Total Exhaust" biological
safety cabinet. These cabinets do not trap gaseous
material in the HEPA filters, since recirculation of these
contaminants inside the cabinet could lead to high
concentrations or loss of containment. Unless ducted to
the outside, these substances would then be introduced
into the laboratory, creating a potential hazard for lab
workers. For example, when working on neural cell lines
and treating those cells with a neurotoxin, the biosafety
cabinet should be ducted to the outside to protect the
user from potential exposure to those toxins.
For product recommendations and suggestions, please
contact your VWR Sales Representative.
Maintaining Cabinet FunCtionality
a biosafety cabinet should be maintained regularly to ensure proper
function at all times. whenever the cabinet will be in use, it should
be turned on for at least five minutes to properly purge the cabinet.
The inside should be wiped down with a 70% ethanol (or other
appropriate decontamination) solution before beginning work.
likewise, everything being placed inside the cabinet that has been
exposed to the ambient room air should also be wiped down.
when the work inside has been completed, the cabinet should be
left to purge for at least five minutes and all surfaces inside wiped
down with a decontamination solution once all materials have been
removed. on a monthly basis the exterior of the cabinet should be
wiped down with a damp cloth.
over time as the hePa filter loads, the reading on the cabinet’s
differential pressure gauge will increase. There should be no major
change in the reading between uses or during use. The cabinet
should be recertified on an annual basis by a qualified certification
technician to check filter condition and airflow. The uV lamp should
be replaced annually if the cabinet or enclosure is so equipped.
find Complete Product listings at
vwr.com
or Call
1.800.932.5000
|
34
34
|
The
EssEntials
of
Tissue Culture
find Complete Product listings at
vwr.com
or Call
1.800.932.5000
|
35
Cell CultiVation
biosafety Cabinets

Biological safety Cabinet, Esco
Certified in More Countries — Esco Lab Culture
•
The safety solution for life science laboratories is available in 3, 4, 5, and 6 foot models
•
Contact your VWR Sales Representative for more ordering options
Description
Cat. No.
Each
4’ Biological Safety Cabinet
97015-936
10,732.22
4’ Telescoping Stand with Leveling Feet
97004-480
971.86
VWR
®
Hand tally Counter
•
Easy-to-use four-digit unit counts up to 9999
•
Protective window seals out dust, dirt, and humidity
•
Features a hinged finger loop for a sure grip
Dia. x W, cm (in.)
Weight, g (oz.)
Cat. No.
Each
4.5 x 3 (1
3
/
4
x1
1
/
8
)
85 (3)
23609-102
37.44
Z series Coulter Counter
®
Cell and
Particle Counters, Beckman Coulter
®
•
Allow for variable, user-specified cell size settings
•
Capable of analyzing virtually all cell types and species variations
•
Use the Coulter Principle (Electrical Sensing Zone Method) of
counting and sizing cells, ensuring accuracy, speed, versatility, and
reproducibility in all applications
•
The Z1
™
Single Threshold model is ideal for obtaining rapid total cell
counts on cell lines containing uniformly sized cells
•
The Z1 Dual Threshold model is ideal when cell numbers between a
selected size range are required
•
The Z2
™
Dual Threshold model provides accurate population size
distribution data
•
Incorporate an oil displacement pump which delivers a high degree
of accuracy and precision, eliminating the need for mercury
•
Certified to ISO 90001 by NSAI Quality Assurance
Description
Cat. No.
Each
Z1 Single Threshold Coulter Counter
CABK6605698
24,671.75
Z1 Dual Threshold Coulter Counter
CABK6605699
32,158.35
Z2 Coulter Counter
CABK6605700
35,731.50
F cus
nformation
IN YouR WoRLD, YouR BIoLoGICAL SAFETY
CABINET SHouLD BE YouR FoRTRESS
When it comes to safety and protection, Esco biological
safety cabinets deliver. Every Esco cabinet is a triumph
of engineering – from the ground up and inside
out. With their durable antimicrobial-coated heavy
gauge sheet metal shells, uLPA filters that are ten
times more efficient than the industry average,
and a certification program second to none in
the industry; Esco cabinets perform, protecting
laboratory personnel day in and day out.
find Complete Product listings at
vwr.com
or Call
1.800.932.5000
|
34
find Complete Product listings at
vwr.com
or Call
1.800.932.5000
|
35
Cell CultiVation
biosafety Cabinets | Cell Counting

Phase Hemacytometer, Hausser scientific
•
Used with a phase microscope for accurately counting red and white blood cells, platelets, dust/yeast clusters, and
specimens in spinal and other body fluids
•
Triple dividing lines clearly show which cells lie within the counting area
•
A "V" cut in the plateau makes filling easy and reduces the possibility of overflow into the moat
•
Each plateau features enhanced Neubauer rulings 0.1mm below the cover glass
Description
Cat. No.
Each
Phase Hemacytometer
15170-263
256.00
inCYtO C-Chip
™
Disposable Hemacytometers, sKC
•
Offer repeatable, reliable measurements and analysis
•
Unique design eliminates the use of coverslips, allowing for exact volume control and reduces risk of exposure
•
Increases efficiency by eliminating the need for washing or autoclaving components
•
Biocompatible and optically transparent
•
Dimensions.. 75L x 25Wmm
•
Thickness.. 1mm
Chamber Depth, µm
Chamber Volume, µL
Grid Type
Cat. No.
Pack of 20
100
10
Burker Turk
82030-482
47.07
100
10
Neubauer Improved
82030-470
47.07
200
20
Fuchs Rosenthal
82030-474
47.07
orFlo
®
Moxi z:
a revolution In Cell Counting
Moxi Z is the only automated cell counter that combines the Coulter Principle typically used in high-
end cell counters with an exclusive thin-film sensor technology to allow particle sizing and counting
for the broadest size range (2–34µm). It also features the Moxi Viability Index (MVI), which provides
an assessment of living cells by measuring the electrical differential between living and dead cells.
•
Precise, repeatable measurements in just eight seconds and easy walk-away operation
•
Accurate, repeatable high-resolution compared to any other cell counter
Description
Cat. No.
Each
MOXI Z Mini Automated Cell Counter Kit
97065-500
3594.00
Accessories
Cassette Dispenser
97065-504
59.40
Cassettes, Type M (2 tests/cassette, 25 cassettes/pack)
97065-502
105.00
Calibration Cassette
97065-510
83.40
Calibration CheckBead Kit
97065-508
107.40
Orflo Diluent
97065-512
11.40
find Complete Product listings at
vwr.com
or Call
1.800.932.5000
|
36
36
|
The
EssEntials
of
Tissue Culture
find Complete Product listings at
vwr.com
or Call
1.800.932.5000
|
37
Cell Counting
Cell Counting

CytoInspect
™
dna Chip, scanned at wavelengths of 532nm (dna probes
fluorescence labeled with Cy3 — green signals) and 635nm (dna probes
fluorescence labeled with Cy5 — red signals), displaying positive results
for the on-Chip Control system and specific mycoplasma probes.
Cytoinspect
™
Mycoplasma Detection test Kits, Greiner Bio-One
Microarray test kits detect mycoplasma contamination in cell cultures and other biological materi-
als. Kits include a universal probe test, as well as species-specific probes to identify virtually all
reported contaminations using PCR detection. Each DNA probe is spotted five times to ensure assay
robustness. On-chip control systems with Cy3- and Cy5-labeling allow for exact quality determina-
tion. Comprehensive assays are completed in under five hours from sample collection to evaluation.
Highly specific and sensitive probes eliminate virtually all false-positive and false-negative test
results. Validated in accordance with European Pharmocopoeia (Ph. Eur. 2.6.21) guidelines. Detection
limit of <10 CFU/mL complies with biologics production requirements.
•
Detection of all Mollicutes with a universal probe
•
Identification of 40 mycoplasma species at species level
•
Comprehensive on-chip-controls and automated data analysis
•
Software designed according to legal requirements of the FDA (21 CFR part 11)
•
High specificity and sensitivity
Description
Cat. No.
Each
CytoInspect Kit, 10 Arrays
89085-680
5638.33
CytoInspect Kit, 60 Arrays
89085-682
33,829.95
CheckScanner Microarray Scanner
89085-684
46,179.18
Additional CheckReport Software License
89085-686
10,055.20
Cell Culture Contamination through Mycoplasma
While bacterial and fungal infections of cell cultures are relatively
easy to detect, prevent and treat, a contamination with mycoplasma
represents a much bigger problem in terms of incidence, detectability,
prevention, eradication and its effects on the final product. It has
been estimated that between 5 to 35% of cell cultures in current use
are infected with mycoplasma.
Contamination with mycoplasma can occur in various stations
throughout the process. So it is important that contamination and
impurity analyses are being performed during processing as well as
upon the final product.
Potential sources of contamination include culture medium compo-
nents such as serum or trypsin as well as contamination from the
laboratory personnel themselves.
Greiner Bio-One developed a specific test kit for rapid detection of
mycoplasma. This system was designed to meet the guidelines for
PCR based mycoplasma detection assays as stated in the European
Pharmacopoeia in July 2007.
The methodology used for our mycoplasma detection assay is based
on microarray technology, which was optimized to allow streamlined
simultaneous analysis of multiple parameters, achieves an accurate
result interpretation. Because the array design includes a set of
integrated DNA universal probes that hybridize to a highly con-
served region of the mycoplasma genome, it is possible to detect the
presence of all mollecute species. In addition to universal detection
capability, the system incorporates species-specific DNA probes to
perform identification of 41 different mycoplasma species, including
the genera Acholeplasma, Ureaplasma and Spiroplasma.
A significant advantage of CytoInspect
™
is that it does not require
Multiplex PCR reactions to differentiate between the 41 myco-
plasma species. Instead, species identification is achieved through
hybridization of fluorescence-labeled PCR amplicons of the 16s-23s
intergenic spacer region to highly species-specific DNA probes within
the array. This is critical, as mycoplasma species identification is
essential to trace the entry point or source of contamination.
An integrated control system enables monitoring of not only sample
quality, but also performance of the test procedure as a whole. This
type of check verification is fundamental for troubleshooting pur-
poses as well as exclusion of both false positive and negative results.
find Complete Product listings at
vwr.com
or Call
1.800.932.5000
|
36
find Complete Product listings at
vwr.com
or Call
1.800.932.5000
|
37
Cell harVesting & disruPtion
mycoplasma detection

Dounce tissue Grinders, Wheaton
•
Designed for fine particle size reduction without damage to cell nuclei
•
For small cells such as
E. coli, proteins, serum, and malignant tissues
•
Made of low extractable borosilicate glass
•
Mortar has large reservoir and pouring lip
•
Large clearance pestle is used for initial sample reduction; narrow clearance pestle
forms the final homogenate
•
Loose pestle clearance.. 0.0889–0.127mm (0.0035–0.0050")
•
Tight pestle clearance.. 0.0254–0.0762mm (0.0010–0.0030")
Capacity, mL
Chamber Dimensions,
D x L, mm
Cat. No.
Case of 2
1
110 x 48
62400-595
174.86
7
130 x 82
62400-620
191.29
15
150 x 82
62400-642
219.87
40
250 x 130
62400-664
273.71
VWR
®
Disposable tissue Grinders
•
Safe and easy to use
•
Patented closed system has the ability to grind specimen in a sealed container,
helping to prevent contact with the sample
•
Molded abrasive surface does not leave any sediment to obstruct examination of
the sample
•
Extra cap and I.D. label are provided for storage, transport, and added safety
•
Fully assembled and gamma sterilized
Capacity, mL
Style
Cat. No.
Case of 10
15
Conical
47732-446
77.84
35
Freestanding
47732-448
89.44
50
Conical
47732-450
90.08
Cell scrapers, Greiner Bio-One
•
Designed for mechanical harvesting of cells in place of chemical treatment methods
•
Pivoting head/blade design minimizes cell damage while ensuring even contact
with growth surface
•
Scraper width.. 18mm
•
Individually wrapped
•
Sterilized by gamma radiation; certified nonpyrogenic
Size
Handle Length, cm (in.)
Cat. No.
Case of 100
Small
25 (9
7
/
8
)
82050-468
148.89
Large
40 (15
3
/
4
)
82050-470
172.64
Cell lifter and scrapers, Corning
•
Lifter features a wide beveled edge for use in cell culture dishes
•
Scraper features an angled swiveled blade for easy access to growth surfaces of
flasks and dishes
•
Individually wrapped
•
Certified nonpyrogenic
Description
Blade Length,
cm (in.)
Handle Length, cm
(in.)
Cat. No.
Case of 100
Cell Lifter
1.9 (
3
/
4
)
18 (7)
29442-200
147.94
Cell Scraper
1.8 (
3
/
4
)
25 (9
7
/
8
)
29442-202
221.09
Cell Scraper
3.0 (1
3
/
16
)
40 (15
3
/
4
)
29442-204
249.73
Cell harVesting & disruPtion
Cell dissociation
find Complete Product listings at
vwr.com
or Call
1.800.932.5000
|
39
38
|
The
EssEntials
of
Tissue Culture

VWR signature
™
Digital Vortex Mixer
•
Ideal for applications that require repeatable performance of speed and time
•
Microprocessor feedback control maintains set speed from 500–3000rpm
•
Timer displays elapsed time or user-defined time limit and shuts off unit when the time reaches zero
•
Can be operated in touch mode or in continuous mode
•
UL and C-UL listed; CE marked
Description
Cat. No.
Each
Digital Vortex Mixer
14005-824
443.54
VWR
®
advanced Heavy-Duty Vortex Mixer
•
A heavy-duty design and efficient motor permit continuous duty operation
•
Unit can handle accessory components over the entire speed range
•
Select from "touch" mode or "on" mode
•
Microprocessor control maintains the set speed for strong, consistent mixing action
•
CSA approved; CE marked
Description
Cat. No.
Each
Heavy-Duty Vortex Mixer
97043-564
961.21
VWR signature
™
Pulsing Vortex Mixer
•
Designed for glass bead procedures and complete cell disruption
•
Unique pulsing action reduces heat generation whle producing excellent grinding action
•
Comes with a micro-tube holder with a built-in cup head allowing the unit to be used as a standard vortex mixer during "touch" mode
•
The digital interface features independent LED displays for both speed and time
•
UL and C-UL listed; CE marked
Description
Cat. No.
Each
Pulsing Vortex Mixer
12620-862
604.68
accessories for VWR
®
and VWR signature
™
Vortex Mixers
•
Microtube and microplate holder kit (
12620-874
) includes a microtube holder (
12620-876
) for forty-eight 0.25–2.0mL microcentrifuge tubes, a microplate holder
(
12620-878
) for a 96- or 384-well plate or deep well block, and an insert retainer (
58816-132
)
•
Tube holder kit (
58816-130
) consists of an insert retainer (
58816-132
) for securing vessels and tube holders, two vessel harnesses (
58816-136
) for flasks and bottles,
one 9–13mm tube holder (
58816-138
) for 5mL culture tubes, one 14–19mm tube holder (
58816-140
) for 15mL centrifuge tubes, and one 20–25mm tube holder
(
58816-142
) for 50mL centrifuge tubes
•
Single tube holder (
12620-898
) mounts on the top of the vortex mixers for hands-free mixing of 15–50mL centrifuge tubes
•
Tube holders (except
12620-898
) require insert retainer
58816-132
Description
Cat. No.
Price
Kits
Microtube and Microplate Holder Kit
12620-874
Ea./
92.96
Tube Holder Kit
58816-130
Ea./
178.37
Holders
Microplate Holder
12620-878
Pk. 2/
53.86
Microtube Holder
12620-876
Pk. 2/
48.20
Single Tube Holder
12620-898
Ea./
131.58
Tube Holder for 5 mL Centrifuge Tubes
58816-138
Pk. 2/
25.79
Tube Holder for 15 mL Centrifuge Tubes
58816-140
Pk. 2/
25.79
Tube Holder for 50 mL Centrifuge Tubes
58816-142
Pk. 2/
25.79
Accessories
Insert Retainer
58816-132
Ea./
118.27
Vessel Harness
58816-136
Pk. 2/
6.89
find Complete Product listings at
vwr.com
or Call
1.800.932.5000
|
39
Cell harVesting & disruPtion
Vortex mixers

F cus
nformation
The rotor recognition system in the 4417 series
provides safety and convenience when different
rotors are used. Each rotor is recognized at the
beginning of a run and automatically limited
to its rated maximum speed. In addition, by
recognizing the rotor, the microprocessor
can accurately calculate and display
g
-force
during a run.
VWR
®
symphony
™
4417/R Centrifuges
•
Compact, space saving design
•
Corrosion resistant, stainless steel rotor chamber
•
Quiet, maintenance-free induction drive
•
Imbalance detection with safety shut down
•
Microprocessor control with splash resistant digital display
•
Accommodates tubes from 0.2mL to 100mL
Description
Cat. No.
Each
Non-Refrigerated Cell Culture Centrifuge Bundle*
89176-490
5949.16
Non-Refrigerated Centrifuge Only
89171-142
3951.80
Refrigerated Cell Culture Centrifuge Bundle*
89176-496
10,087.25
Refrigerated Centrifuge Only
89171-144
8089.91
*Bundles include the centrifuge with a 4 x 100mL swing-out rotor and carriers for 15mL and 50mL conical tubes
Vwr offers a wide variety of centrifuges to fit every application. find the right centrifuge and centrifuge
tubes for your needs at vwr.com.
find Complete Product listings at
vwr.com
or Call
1.800.932.5000
|
40
40
|
The
EssEntials
of
Tissue Culture
find Complete Product listings at
vwr.com
or Call
1.800.932.5000
|
41
Cell harVesting & disruPtion
Centrifuges

VWR
®
superClear
™
Ultra-High Performance Centrifuge tubes
•
Leakproof, polypropylene tubes feature printed graduations and smooth inner walls for easy filling
and sample preparation
•
Printed writing area on side allows for permanent coding
•
Autoclavable at 122°C (251.6°F); Freezable to –90°C (–130°F)
•
Thick-wall construction for high-speed operation
•
Flat caps provide an additional labeling surface
•
Racks are made from Earth Friendly
®
recyclable plastic
•
Leakproof
•
DNase-, RNase-, and endotoxin-free
•
Validated ISO 11137 Sterile Process
Sterility
Packaging
Cat. No.
Case of 500
15mL Tubes
Nonsterile
50/Bag, 10 Bags/Case
21008-214
140.21
Nonsterile
25/Rack, 2 Racks/Pack, 10 Packs/Case
21008-089
166.07
Nonsterile
Bulk
21008-105
145.77
Sterile
50/Bag, 10 Bags/Case
21008-216
155.92
Sterile
25/Rack, 2 Racks/Pack, 10 Packs/Case
21008-103
174.99
50mL Tubes
Nonsterile
50/Bag, 10 Bags/Case
21008-240
172.91
Nonsterile
25/Rack, 20 Racks/Case
21008-169
202.13
Nonsterile
Bulk
21008-177
144.47
Sterile
50/Bag, 10 Bags/Case
21008-242
166.71
Sterile
25/Rack, 20 Racks/Case
21008-178
200.83
vWr
CaTalysT site service solutions
can help you keep your researchers and staff focused on your
needs and goals, new development, and competitive edge.
Services
Coordinator
Scheduled
Calibrations
Installations
Qualifications
Equipment &
Instrument
Libraries
Asset
Tracking &
Usage Audits
Compliance
Services
Protocol
Developement
Vendor
Consolidation &
Management
Validations
(IQ, OQ, PQ)
OEM -Warranty
Coordination
Researchers
Equipment & Instrument Services Solutions
VWR
CATALYST
Asset
Management
over the past 20 years we have performed
hundreds of on and offsite services for our
clients every day and have become the
industry benchmark for those services. From
autoclaving to warehouse management,
and virtually every service in between,
Vwr
CATALYST can answer all of your site
service needs.
Keep your eye on the prize and let
vWr
CaTalysT site
services perform those essential but non-core tasks that
distract your staff from their core mission.
for more information, contact
vWr
CaTalysT by calling
1.888.793.2300
or emailing
vwr
catalyst
@vwr.com
find Complete Product listings at
vwr.com
or Call
1.800.932.5000
|
40
find Complete Product listings at
vwr.com
or Call
1.800.932.5000
|
41
Cell harVesting & disruPtion
Centrifuges

Polyplus-transfection is committed to providing you the very best tools and solutions
for cell transfection. They guarantee the product performance and quality you need
by developing, testing, and manufacturing their reagents in their own dedicated and
ISo-accredited facilities.
These reagents are robust, deliver high efficiency, and are compatible with serum and
antibiotics. Contact your VWR Sales Representative for complete details and pricing.
jetPRiME
™
Dna & siRna transfection
Reagent, Polyplus-transfection
•
Powerful transfection reagent that is gentle to cells
•
Versatile use in both DNA & siRNA transfection
•
High DNA transfection efficiency (see Fig. 1)
•
Economical formula uses only a small amount of reagent
and DNA per reaction (see Table 1)
•
Comes with a specific buffer, so is ready to use
Buffer Concentration
Size, mL
Cat. No.
Each
1X
0.75
CA89129-922
222.64
1X
1.5
CA89129-924
378.40
1X
5 x 1.5
CA89129-926
1701.04
5X
5 x 1.5
CA89137-972
1630.64
intERFERin
™
siRna transfection
Reagent, Polyplus-transfection
•
Great silencing at 1nM for reliable results
•
Over 90% gene silencing in a wide range of cell types
•
Excellent cell viability
•
INTERFERin-HTS is specifically designed for automated procedures
Size, mL
Cat. No.
Each
INTERFERin Reagent
1
CA89129-930
181.28
5 x 1
CA89129-932
708.40
INTERFERin-HTS Reagent
1.5
CA89137-968
396.00
4 x 1.5
CA89137-970
1425.60
jetPEi
™
Dna transfection Reagent for High
troughput screening, Polyplus-transfection
•
Exceptionally reproducible results
•
Well suited for high-throughput screening, especially plasmid and shRNA libraries
•
Stable up to four hours when combined with DNA
•
Variety of protocols to fit your needs
Size, mL
Cat. No.
Each
jetPEI Reagent
1
CA89129-938
235.84
4 x 1
CA89129-940
836.00
10
CA89137-958
2000.24
jetPEI Reagent plus Sodium Chloride Solution
1
CA89129-916
253.44
4 x 1
CA89129-918
887.04
10
CA89137-960
2068.00
in vivo-jetPEi
™
Delivery Reagents,
Polyplus-transfection
•
Provides successful and reproducible delivery of DNA, siRNA, and oligonucleotides
in vivo
•
Multiple modes of administration in many species
•
Reagent of choice for functional studies, RNA interference, gene therapy, and
genetic vaccination
•
Does not cause any detectable inflammatory response at therapeutic doses
•
Comes with a glucose solution
Size, mL
Cat. No.
Each
in vivo-jetPEI Reagent
0.1
CA89129-960
350.24
0.5
CA89129-962
1268.08
F cus
nformation
THE DELIVERY EXPERTS
fig. 1
Table 1
find Complete Product listings at
vwr.com
or Call
1.800.932.5000
|
42
42
|
The
EssEntials
of
Tissue Culture
find Complete Product listings at
vwr.com
or Call
1.800.932.5000
|
43
Cell harVesting & disruPtion
Transfection

BtX
™
ECM
®
830 square Wave Electroporation
system, Harvard apparatus
•
Designed for all in vitro and in vivo applications
•
Square wave pulse shaping leads to higher viability and efficiency of the testing
material
•
Low voltage mode offers 1V discrimination and ±5% accuracy
•
Generator is short-circuit proof and features RS-232 and RS-485 interface ports
•
Arc Quenching
™
mechanism minimizes sample damage due to arcing
•
Pulse length.. 10μs–10sec
•
Meets CE requirements
Description
Cat. No.
Each
Electroporation System
58018-004
9351.50
Generator Only
47745-928
8646.71
BtX
™
ECM
®
630 Exponential Decay Wave
Electroporation system, Harvard apparatus
•
Features power platform technology, instant feedback, and on-line menu
•
Time constant is easily and precisely controlled with the Precision Pulse
™
system
•
Over 200 ECM 630 protocols can be duplicated, as well as additional competitive
protocols with the use of the resistor selection "NONE"
•
Parameter settings are simplified with the single dial control
•
Meets CE requirements
Description
Cat. No.
Each
Electroporation System with Cuvettes
58017-932
7749.96
Electroporation System with 96-Well Plates
47745-926
7005.56
Generator Only
82019-202
10,358.21
FoCus on your Core
aCtiVities and MaxiMize your
ProduCtiVity with
vWr
CaTalysT.
vWr
CaTalysT offers a full portfolio of validation and
calibration services to cover all of your preventative
maintenance needs, as well as other services such
as chemical inventory management, supply chain
management, and logistical support. Contact your Vwr
sales representative or call
1.888.793.2300
for more
information on
vWr
CaTalysT.
find Complete Product listings at
vwr.com
or Call
1.800.932.5000
|
42
find Complete Product listings at
vwr.com
or Call
1.800.932.5000
|
43
Cell harVesting & disruPtion
Transfection

nalgene
®
Cryogenic Vials with
Bar Code, thermo scientific
•
For storage in mechanical and vapor-phase liquid
nitrogen freezers
•
Chemically resistant bar codes make these vials
ideal for automated data collection, sample
inventory, or identity masking
•
Self-standing vials made of polypropylene with
polyethylene closures
•
Certified sterile, noncytotoxic, and nonpyrogenic
•
Temperature Range.. –40 to 121°C
Capacity, mL
O.D. x H, mm
Packaging/Bag
Cat. No.
Case of
1.2
13.5 x 38.4
25
73521-052
500/
357.32
2
13.5 x 48.5
25
73521-054
500/
357.32
5
13.5 x 89.4
10
73521-056
250/
273.69
nalgene
®
Cryogenic Vials,
thermo scientific
•
Polypropylene vials are ideal for storage in
mechanical and vapor-phase liquid nitrogen
freezers
•
Screw cap comes with a sealing ring to ensure
secure closure
•
External thread position greatly reduces risk of
contaminating contents
•
Deep-skirted closure allows single-handed aseptic
technique without exposing fingers to contents
•
Convenient filling through large inner diameter
of vial
•
Sterilized by gamma radiation; certified
noncytotoxic, and nonpyrogenic
•
Temperature Range.. –40 to 121°C
Volume, mL
O.D. x H, mm
Packaging
Cat. No.
Case of
1.2
13.5 x 38.1
25/Bag
66008-706
500/
298.67
1.2
13.5 x 38.1
Bulk
66008-751
1000/
522.41
2.0
13.5 x 48.3
25/Bag
66008-728
500/
298.67
2.0
13.5 x 48.3
Bulk
66008-754
1000/
522.41
5.0
13.5 x 92
10/Bag
66008-732
25/
242.64
nunc
®
Cryobank Cryogenic storage
Vials, thermo scientific
•
Vials snap into a 96-place automation-compatible rack, providing
automated manipulation and safe transport
•
Internally threaded caps feature a socket to allow opening and closing
with a screwdriver
•
Optional 2D code is laser-etched into the polypropylene bottom of the
vial to prevent loss during storage
•
Feature low protein adsorption and are ideal for cells and proteins
•
DNAse- and RNAse-free and nontoxic according to USP class VI test
•
Sterile and pyrogen-free; CE marked
•
Temperature Range.. –40 to 121°C
Volume, mL
Cat. No.
Case of 960
Uncoded
0.5
CA82030-512
510.36
2D Coded
0.5
CA82030-510
627.13
1.0
CA82030-518
700.62
nunc
®
Cryotube
®
Vials with internal
thread, thermo scientific
•
Designed for cryogenic storage of cells, blood, serum, and other biological specimens
•
Polypropylene tubes perform well in mechanical and liquid nitrogen freezers
•
Silicone-gasketed screw caps stay sealed at extreme temperatures (–40 to 121°C)
•
Starfoot-style vials permit one-hand operation when used with CryoTube racks
•
Passed 95kPa testing for IATA requirements
•
12.5mm dia.
•
Sterile
Volume, mL
Style
Cat. No.
Pack of
Non-Self-Standing Vials
1.8
Round-Bottom
CA
66021-985
500/
295.66
4.5
Round-Bottom
CA
66021-990
A
300/
276.94
3.6
Round-Bottom
CA
66021-988
400/
313.26
Skirted Self-Standing Vials
1.0
Conical-Bottom
CA
66021-992
500/
295.66
1.8
Round-Bottom
CA
66021-987
450/
265.74
Starfoot Self-Standing Vials
1.0
Conical-Bottom
CA
66021-993
500/
295.66
1.8
Round-Bottom
CA
66021-986
A
450/
265.74
4.5
Round-Bottom
CA
66021-991
300/
276.94
3.6
Round-Bottom
CA
66021-989
400/
313.26
find Complete Product listings at
vwr.com
or Call
1.800.932.5000
|
44
44
|
The
EssEntials
of
Tissue Culture
find Complete Product listings at
vwr.com
or Call
1.800.932.5000
|
45
CryoPreserVation
Cryovials

ordering ProduCts is easy through Vwr.CoM
our web site gives you maximum control over the ordering process. with all of the available
options, you can simplify your purchasing process by matching it to your own business practices.
nunc
®
Cryotube
®
Vials with External thread,
thermo scientific
•
Polypropylene vials are designed for cryogenic storage
of cell cultures, sperm, blood, and serum specimens
•
Perform well in mechanical and liquid nitrogen freezers
•
External-threaded screw cap reduces risk of
contamination from handling
•
Freestanding starfoot vials have a 12.5mm diameter
with a 13mm diameter cap
•
Stepneck vials and caps have a 12.4mm diameter
•
Passed 95kPa testing for IATA requirements
•
Sterile
•
Temperature Range.. –40 to 121°C
Description
Volume, mL
Cat. No.
Pack of
Round-Bottom
Stepneck with Marking Area
1.8
CA
66021-997
500/
284.27
Starfoot Vials with Marking Area
1.8
CA
66021-996
450/
256.19
Starfoot Vials with Marking Area
4.5
CA
66021-984
300/
276.32
Conical-Bottom
Starfoot Vials with Marking Area
1.0
CA
66021-994
500/
284.27
nalgene
®
sYstEM 100
™
Cryogenic
Vials, thermo scientific
•
Self-standing to increase storage capacity
•
Polypropylene construction withstands temperatures
from –40 to 121°C
•
Silicone gasketed closures ensure leakproof performance
•
Externally threaded vials for aseptic technique
•
Sterile, noncytotoxic, and nonpyrogenic
•
Self-standing
•
CE marked
Capacity, mL
O.D. x H, mm
Cat. No.
Case of 500
1.0
12 x 38
66008-708
306.30
1.5
12 x 48
66008-710
306.30
1.5 with Bar Code
12 x 48
73521-058
379.04
VWR
®
Cryogenic Vials with Closures
•
Special base design allows them to be locked into a cryogenic rack and tray for single-handed
manipulation
•
Graduation marks and a large marking spot for easy labeling of contents
•
Can be color-coded with cap inserts, sold separately
•
Polypropylene vials can withstand temperatures to –196°C (–321°F)
•
DNase- and RNase-free, nonpyrogenic, sterile
Capacity, mL
Thread
Cat. No.
Case of 500
Conical-Bottom, Self-Standing
1.2
External
89094-800
137.69
1.2
Internal
89094-802
131.12
Round Bottom
2
External
89094-808
139.95
2
Internal
89094-804
133.27
4
Internal
89094-814
150.49
5
Internal
89094-820
194.62
Round Bottom, Self-Standing
2
External
89094-806
139.95
2
Internal
89094-810
133.27
4
External
89094-812
158.01
4
Internal
89094-816
150.49
5
External
89094-818
183.71
5
Internal
89094-822
174.83
find Complete Product listings at
vwr.com
or Call
1.800.932.5000
|
44
find Complete Product listings at
vwr.com
or Call
1.800.932.5000
|
45
CryoPreserVation
Cryovials

F cus
nformation
CryoElitE
™
Cryogenic Vials, WHEatOn
•
2mL vials are made from low binding, cryogenic grade, virgin polypropylene
•
Colored caps match CryoFile
™
storage box colors to easily color code projects
•
Cap seal exceeds DOT and IATA regulations for ultimate sample protection during transportation and
freeze-thaw cycles
•
Loctagon
™
vial skirt provides stability in freestanding position for easy open and closing with one hand
•
Bottom format allows unrestricted view of the optional 2D bar code for automated screening
•
Dimensions for external thread vials.. 12x50mm; dimensions for internal thread vials.. 12x49mm
Cap Color
Writing Patch
Sterile
Cat. No.
Case of
Vials with External Thread
Natural
No
No
89125-492
1000/
267.33
Natural
Yes
No
89125-490
1000/
327.98
Natural
Yes
Yes
89125-512
500/
172.48
Blue
Yes
Yes
89125-510
500/
172.48
Green
Yes
Yes
89125-508
500/
172.48
Pink
Yes
Yes
89125-504
500/
172.48
Red
Yes
Yes
89125-502
500/
172.48
White
Yes
Yes
89125-500
500/
172.48
Yellow
Yes
Yes
89125-506
500/
172.48
Vials with Internal Thread
Natural
No
No
89125-452
1000/
267.33
Natural
Yes
No
89125-450
1000/
327.98
Natural
Yes
Yes
89125-478
500/
172.58
Blue
Yes
Yes
89125-476
500/
172.58
Green
Yes
Yes
89125-474
500/
172.58
Pink
Yes
Yes
89125-470
500/
172.58
Red
Yes
Yes
89125-468
500/
172.58
White
Yes
Yes
89125-466
500/
172.58
Yellow
Yes
Yes
89125-472
500/
172.58
CryoElitE
™
2D Data Matrix Bar Code
Bottom inserts, WHEatOn
•
Optional insert allows for immediate bar coding of samples
•
Can also be applied to the vial at a future date
•
Insert easily press fits and locks into the bottom of the vial
Sterile
Cat. No.
Case of 500
Yes
89134-436
199.75
No
89134-438
194.53
Vials with External Thread
Vials with Internal Thread
CryoFile
™
storage Boxes, WHEatOn
using a color coded system to identify different sample
groups is a fast and easy way to minimize freezer
fluctuations and maximize your efficiency in the lab. When
you match your CryoELITE vial cap color to the CryoFile
storage box color, you can visually identify specific lots and
be in and out of the freezer in much less time.
•
Colors match CryoELITE vials for easy sample
identification
•
Partitions are numbered from 1–81 with the
numbering system printed on both the lid and the
bottom of the box
•
Lids provide space to write additional sample
information
•
Fits 1.2 and 2mL vials
•
Water-repellent material provides longer durability
•
Boxes withstand temperatures down to –196°C
•
Dimensions.. 13L x 13W x 5.2Hcm (5
1
/
8
x 5
1
/
8
x 2")
Color
Cat. No.
Case of 15
Blue
89092-392
77.93
Green
89092-376
77.93
Pink
89092-380
77.93
Red
89092-396
77.93
White
89092-388
77.93
Yellow
89092-384
77.93
find Complete Product listings at
vwr.com
or Call
1.800.932.5000
|
46
46
|
The
EssEntials
of
Tissue Culture
find Complete Product listings at
vwr.com
or Call
1.800.932.5000
|
47
CryoPreserVation
Cryovials | labels & storage

VWR
®
CryoPro
®
storage Boxes and Dividers
•
Durable fiberboard construction with a protective, moisture-repellant coating
•
Liquid nitrogen freezer boxes feature slots for safe drainage and reduced consumption
•
Boxes with dividers feature a lid with a numbered grid for superior inventory control
•
Boxes without dividers can accommodate dividers (sold separately) for 16 to 100 places
•
Dividers can fit in any 12.7x12.7cm (5x5") LN
2
cryogenic or mechanical freezer box
Dimensions, L x W x H, cm (in.)
No. of Places
Cat. No.
Price
Liquid Nitrogen Cryogenic Freezer Boxes with Drain Slots
7 x 7 x 5.1 (2
3
/
4
x 2
3
/
4
x 2)
25
82007-160
Cs. 204/
1098.34
12.7 x 12.7 x 5.1 (5 x 5 x 2)
81
97014-322
Cs. 120/
634.01
12.7 x 12.7 x 5.1 (5 x 5 x 2)
100
82007-158
Cs. 120/
435.11
Mechanical Cryogenic Freezer Boxes
12.7 x 12.7 x 5.1 (5 x 5 x 2)
−
82021-114
Pk. 12/
41.17
12.7 x 12.7 x 5.1 (5 x 5 x 2)
−
82007-142
Cs. 120/
366.39
12.7 x 12.7 x 5.1 (5 x 5 x 2)
81
82007-162
Cs. 120/
361.86
12.7 x 12.7 x 7.6 (5 x 5 x 3)
−
82021-116
Pk. 12/
49.98
12.7 x 12.7 x 7.6 (5 x 5 x 3)
−
82007-144
Cs. 120/
361.86
Fiberboard Dividers
12.7 x 12.7 x 2.5 (5 x 5 x 1)
16
82021-118
Pk. 12/
23.27
12.7 x 12.7 x 2.5 (5 x 5 x 1)
25
82021-120
Pk. 12/
23.27
12.7 x 12.7 x 2.5 (5 x 5 x 1)
49
82021-122
Pk. 12/
23.27
12.7 x 12.7 x 2.5 (5 x 5 x 1)
64
82021-124
Pk. 12/
22.59
12.7 x 12.7 x 2.5 (5 x 5 x 1)
81
82021-126
Pk. 12/
19.20
12.7 x 12.7 x 2.5 (5 x 5 x 1)
100
82021-128
Pk. 12/
23.27
aspects of Cryopreservation
arne Johansson, senior scientist, Thermo scientific
fig. 1
Cryoflex protective
tubing used as a "cane"
for lowering CryoTubes
into liquid nitrogen.
A variety of types and brands of
vials are used for the storage of
biological materials at low tem-
perature. The purpose of storage
at low temperature is to keep and
maintain materials for later use, e.g.,
to preserve original cells for later
culture. It is of great importance that
the storage vials do not cause any
change or damage to the sample,
which is often irreplaceable.
When choosing a suitable vial or
container for cryopreservation,
the following aspects should be
considered:
•
Tightness
•
Toxicity
•
Mutagenicity
•
Pyrogenicity
•
Sterility
•
Tightness
For long term storage of samples,
particularly in liquid nitrogen, a
completely leak proof seal is needed.
If liquid nitrogen enters the vial
during storage, the vial may explode
when it is thawed due to vaporiza-
tion of the liquid nitrogen inside the
vial. When heated to room tempera-
ture, liquid nitrogen will expand
about 700 times, or create a pressure
of about 700 atmospheres if expan-
sion is prohibited! At ultralow
temperatures, any sealing material
becomes inflexible, so there is always
a theoretical risk of leakage when a
mechanical closure is used.
To avoid the risk of vials that have
been stored in liquid nitrogen
exploding, they may be kept in the
gas phase in the nitrogen container
for a minimum of 24 hours before
removal to higher temperatures.
This will allow any liquid nitrogen
present to boil off slowly thus
preventing the dramatic expansion
described above. To ensure 100%
leak proof storage, mechanically
closed containers must be hermeti-
cally sealed in an outer protective
envelope.
Toxicity
In order to preserve the viability of
living samples, such as cultured cells,
possibly for years, it is necessary that
the vial material is absolutely non-
toxic. Plastic vials are commonly
used for storing such samples at low
or ultralow temperatures. However,
the choice of plastic grade for these
vials is very critical as some grades
may contain impurities or addi-
tives, which are toxic to cells. When
choosing vials for cryopreservation,
proven non-toxicity of the vial mate-
rial is therefore of great importance.
Mutagenicity
As one purpose of storing samples,
including cultured cells, is to main-
tain a reference stock of unaltered
material, consideration should be
given to the possible mutagenic
effect of components that may be
absorbed from the vial. It should be
noted that the effect of mutagenic
components absorbed during storage
may only be expressed after a
number of post-storage cell divisions,
as mutagenesis is a long term effect
on life processes, which are brought
to a standstill during storage. Thus,
the results of mutagenicity may not
appear until the cells have been
subcultured several times.
Pyrogenicity
Cryopreservation vials may be used
for the storage of substances used in
pharmacological studies. Pyrogenic
impurities released from the vial are
unacceptable because they could
possibly interfere with the effects of
pharmacological substances. Endo-
toxins are known to be especially
adsorptive to polypropylene, the
type of plastic used for cryopreser-
vation vials. One should therefore
pay special attention to the possible
presence of these pyrogens.
Sterility
To maintain the integrity of the stored
material, it must be free from contam-
ination with foreign micro-organisms.
A proven Sterility Assurance Level
(SAL) is another important criterion
for the choice of vial.
find Complete Product listings at
vwr.com
or Call
1.800.932.5000
|
46
find Complete Product listings at
vwr.com
or Call
1.800.932.5000
|
47
CryoPreserVation
labels & storage

Omnisolv
®
Dimethyl sulfoxide, EMD Millipore
Assay (by GC):
99.9% min.
Synonyms:
DMSO; Methyl Sulfoxide
CAS No.:
67-68-5
Merck Index:
13.329
Formula:
(CH
3
)
2
SO
Formula Weight:
78.13
Density:
1.10 g/L
Size, L
Packaging
Cat. No.
Case of
1
Poly-Coated Glass Bottle
CAMX1456P-6
6/
307.94
4
Glass Bottle
CAMX1456-1
4/
318.04
4
Poly-Coated Glass Bottle
CAMX1456P-1
4/
843.47
seraFree
™
Cryopreservation Media, aMREsCO
•
Suitable for use in environments that prohibit the use of animal-derived products
•
Optimized for cell viability and growth after thawing
•
Reduces the potential for transmission of infectious agents
•
Available in RPMI or DMEM media formulations
•
Tested for sterility and endotoxins
Description
Size, mL
Cat. No.
Each
DMEM Cryopreservation Media
6 x 5
CA97063-280
18.79
RPMI Cryopreservation Media
50
CA97063-272
36.13
VWR
®
Cryogenic Dot and strip labels
•
Ideal for all cryostorage, liquid nitrogen, refrigeration, and ultra-low temperature freezer applications
•
Can be placed in most incubators
•
Features a unique adhesive that can withstand extreme temperatures from –196 to 121°C (–321 to 250°F)
without the need for lamination
Description
Dimensions, WxH mm (in.) Color
Packaging
Cat. No.
Case of
Rolls of Labels
Dots for 0.5–1.5 mL Tubes
9.5 (
3
/
8
) dia.
White
Roll of 1000
89097-576
1000/
52.19
Dots for 0.5–1.5 mL Tubes
9.5 mm (
3
/
8
) dia.
Multicolor
Roll of 5000
89097-584
5000/
170.45
Dots for 1.5–2 mL Tubes
13 (
1
/
2
) dia.
White
Roll of 1000
89097-580
1000/
54.85
Strips for 1.5–2 mL Tubes
33 x 13 (1
1
/
4
x
1
/
2
)
White
Roll of 1000
89097-574
1000/
54.85
Boxes of Laser Printer Label Sheets
Dots for 0.5–1.5 mL Tubes
9.5 (
3
/
8
) dia.
White
20 Sheets, 192/Sheet
89097-590
20/
91.83
Strips for 0.5 mL Tubes
24 x 13 (1 x
1
/
2
)
White
20 Sheets, 119/Sheet
89097-582
20/
106.38
Strips for 1.5–2 mL Tubes
33 x 13 (1
1
/
4
x
1
/
2
)
White
20 Sheets, 85/Sheet
89097-572
20/
109.94
Strips for 1.5–2 mL Tubes
33 x 13 (1
1
/
4
x
1
/
2
)
Multicolor
25 Sheets, 85/Sheet
89097-588
25/
170.47
Strips for Racks or Boxes
67 x 25 (2
5
/
8
x 1)
White
20 Sheets, 30/Sheet
89097-578
20/
90.69
VWR
®
CryoPro
®
Rack systems, BR series
•
The perfect solution for medium to large storage needs
•
Allows for quick and accurate inventorying and recovery of specimens
•
BR-1 model can hold 25-cell cardboard or plastic boxes
•
BR-2, -3, and -4 models can hold 100-cell cardboard or plastic boxes
•
Rollerbases are available for safely moving full tanks
Description
Dimensions, H x O.D.,
cm (in.)
Liquid Nitrogen
Capacity, L
Neck Diameter,
cm (in.)
Static Evaporation
Rate, L/Day
Cat. No.
Each
BR-1 Rack System
67.3 x 50.8 (26
1
/
2
x 20)
47
12.7 (5)
0.39
55709-208
2846.46
BR-2 Rack System
68 x 55.9 (26
3
/
4
x 22)
61
21.6 (8
1
/
2
)
0.85
55709-210
4432.97
BR-3 Rack System
95 x 55.9 (37
3
/
8
x 22)
121
21.6 (8
1
/
2
)
0.99
55709-212
5107.23
BR-4 Rack System
95 x 65.5 (37
3
/
8
x 26
3
/
16
)
175
21.6 (8
1
/
2
)
0.99
55709-214
5901.22
find Complete Product listings at
vwr.com
or Call
1.800.932.5000
|
48
48
|
The
EssEntials
of
Tissue Culture
find Complete Product listings at
vwr.com
or Call
1.800.932.5000
|
49
CryoPreserVation
labels & storage | Cryoreagents

VWR
®
CryoPro
®
liquid Dewars, l series
•
Conveniently store and dispense large or small quantities of liquid nitrogen
•
Customize to your specific application with accessories (available separately)
Description
O.D. x H, cm (in.)
Liquid Nitrogen
Capacity, L
Neck Diameter
cm (in.)
Static Evaporation
Rate, L/Day
Weight Empty,
kg (lbs.)
Weight Full,
kg (lbs.)
Cat. No.
Each
L-4 Liquid Dewar
18.5 x 42.6
(7
1
/
4
x 16
3
/
4
)
4
3.5 (1
3
/
8
)
0.19
2.7 (6)
6 (13)
82021-112
875.26
L-5 Liquid Dewar
22.2 x 46.2
(8
3
/
4
x 18
3
/
16
)
5
5.6 (2
3
/
16
)
0.15
4 (8.8)
8 (17.6)
55709-234
794.95
L-10 Liquid Dewar
26 x 54.6
(10
1
/
4
x 21
1
/
2
)
10
5.6 (2
3
/
16
)
0.18
6 (13.2)
14 (30.9)
55709-236
856.98
L-20 Liquid Dewar
36.8 x 62.7
(14
1
/
2
x 24
11
/
16
)
21
5.1 (2)
0.18
9 (19.8)
26 (57.3)
55709-238
1074.43
L-30 Liquid Dewar
43.2 x 61.1 (17 x 24)
32
6.4 (2
1
/
2
)
0.22
12 (26.4)
38 (83.8)
55709-240
1211.48
L-50 Liquid Dewar
43.2 x 77.9
(17 x 30
11
/
16
)
50
6.4 (2
1
/
2
)
0.49
15 (33)
56 (123.5)
55709-242
1606.17
VWR
®
CryoCooler Freeze Controller
•
Polycarbonate freeze controller provides the 1°C/min. cooling rate required for successful cell preservation
•
Floating rigid insert helps prevent contamination
•
Holds up to eighteen 1.2–2mL cryogenic vials
Description
Cat. No.
Each
CryoCooler
414004-284
50.20
did you know?...
Vwr "Center of excellence" lab and field technicians
are Iso 9001 certified and Iso/IeC 17025 compliant.
To learn more call
1.888.793.2300
or email
vwrcatalyst@vwr.com
find Complete Product listings at
vwr.com
or Call
1.800.932.5000
|
48
find Complete Product listings at
vwr.com
or Call
1.800.932.5000
|
49
CryoPreserVation
liquid nitrogen | freeze Controllers

VWR signature
™
Ultra-low temperature Freezers
•
Audible alerts to unsafe conditions
•
Advanced microprocessor control to simplify programming, set-up, and monitoring
•
Increased reserve of BTUH capacity for greater energy efficiency
•
Automatic low voltage compensation minimizes wear on compressors
•
Temperature range.. –86 to –50°C (–123 to –58°F)
Volume, L (cu. ft.)
Electrical
Interior Dimensions,
H x W x D, cm (in.)
Exterior Dimensions,
H x W x D, cm (in.)
Shipping Weight,
kg (lbs.)
Cat. No.
Each
Upright Freezers
368 (13)
120V, 60 Hz
131 x 58 x 49 (51
1
/
2
x 23 x 19
5
/
16
)
198 x 85 x 79 (78 x 33
1
/
2
x 31)
313 (690)
14230-104
13,397.76
368 (13)
230V, 50/
60 Hz
131 x 58 x 49 (51
1
/
2
x 23 x 19
5
/
16
)
198 x 85 x 79 (78 x 33
1
/
2
x 31)
313 (690)
14230-102
13,397.76
490 (17.3)
120V, 60 Hz
131 x 58 x 64 (51
1
/
2
x 23 x 25
3
/
16
)
198 x 85 x 94 (78 x 33
1
/
2
x 37)
358 (790)
14230-106
13,753.74
490 (17.3)
230V, 50/
60 Hz
131 x 58 x 64 (51
1
/
2
x 23 x 25
3
/
16
)
198 x 85 x 94 (78 x 33
1
/
2
x 37)
358 (790)
14230-108
13,753.74
650 (23)
120V, 60 Hz
131 x 78 x 64 (51
1
/
2
x 30
3
/
4
x 25
3
/
16
)
198 x 104 x 94 (78 x 41 x 37)
390 (860)
53516-568
16,246.66
650 (23)
230V, 50/
60 Hz
131 x 78 x 64 (51
1
/
2
x 30
3
/
4
x 25
3
/
16
)
198 x 104 x 94 (78 x 41 x 37)
390 (860)
14230-110
16,246.66
793 (28)
230V, 50/
60 Hz
131 x 93 x 69 (51
1
/
2
x 36
5
/
8
x 27
1
/
8
)
198 x 119 x 94 (78 x 47 x 37)
445 (980)
97014-798
19,119.15
Chest Freezers
85 (3)
120V, 60 Hz
42 x 47 x 47 (16
1
/
2
x 18
1
/
2
x 18
1
/
2
)
111 x 72 x 73 (43
3
/
4
x 26
1
/
2
x 28
3
/
4
)
159 (350)
14230-112
9104.54
359 (12.7)
120V, 60 Hz
71 x 108 x 47 (28 x 43
1
/
2
x 18
1
/
2
)
103 x 183 x 73 (40
1
/
2
x 72 x 28
3
/
4
)
338 (745)
14230-122
12,580.80
359 (12.7)
230V, 50/
60 Hz
71 x 108 x 47 (28 x 43
1
/
2
x 18
1
/
2
)
103 x 183 x 73 (40
1
/
2
x 72 x 28
3
/
4
)
338 (745)
14230-120
12,353.19
566 (20)
120V, 60 Hz
71 x 169 x 47 (28 x 66
1
/
2
x 18
1
/
2
)
103 x 244 x 73 (40
1
/
2
x 96 x 28
3
/
4
)
386 (852)
14230-130
13,149.83
566 (20)
230V, 50/
60 Hz
71 x 169 x 47 (28 x 66
1
/
2
x 18
1
/
2
)
103 x 244 x 73 (40
1
/
2
x 96 x 28
3
/
4
)
386 (852)
14230-128
13,149.83
VWR
®
symphony
™
Ultra-low temperature Freezers
•
Audible, visual, and mobile messaging alarm options available
•
Vacuum thermal insulation technology increases storage space
•
Four gasketed inner doors are standard, creating compartments that can be further subdivided with adjustable shelves
•
Temperature range.. –86 to –50°C (–123 to –58°F)
•
Three-year warranty on parts and labor and a five-year warranty on the compressor
•
UL and C-UL listed
Volume, L (cu. ft.)
Electrical
Interior Dimensions,
H x W x D, cm (in.)
Exterior Dimensions,
H x W x D, cm (in.)
Shipping Weight, kg (lbs.)
Cat. No.
Each
626 (22)
115V, 60 Hz
131 x 76 x 63
(51
1
/
2
x 30 x 24
13
/
16
)
197 x 91 x 83.5
(77
1
/
2
x 35
13
/
16
x 33)
350 (772)
414005-088
12,911.36
626 (22)
220V, 60 Hz
131 x 76 x 63
(51
1
/
2
x 30 x 24
13
/
16
)
197 x 91 x 83.5
(77
1
/
2
x 35
13
/
16
x 33)
350 (772)
414005-087
12,911.36
722 (25.4)
220V, 60 Hz
131 x 87 x 63
(51
1
/
2
x 34
1
/
4
x 24
13
/
16
)
197 x 91 x 115
(77
1
/
2
x 35
13
/
16
x 45
1
/
8
)
370 (816)
414004-216
12,140.94
810 (28.6)
220V, 60 Hz
131 x 87 x 71
(51
1
/
2
x 34
1
/
4
x 28)
198 x 114.6 x 98
(77
7
/
8
x 45
1
/
8
x 38
5
/
8
)
380 (837)
414004-658
16,678.80
find Complete Product listings at
vwr.com
or Call
1.800.932.5000
|
50
50
|
The
EssEntials
of
Tissue Culture
find Complete Product listings at
vwr.com
or Call
1.800.932.5000
|
51
CryoPreserVation
freezers

ANTIBIoTICS
ELECTRoPoRATIoN SYSTEMS
CELL CuLTuRE SYSTEMS
CELLuLAR ASSAYS
CENTRIFuGATIoN
CRYoPRESERVATIoN
ELECTRoCoMPoNENT CELLS
ANTIBoDIES
ELISA
FILTRATIoN
PIPETTING
SHAKERS
TRANSFECTIoN REAGENTS
INCuBAToRS - Co
2
CELL CouNTERS
BIoLoGICAL SAFETY CABINETS
VWR is continually expanding our portfolio to support your research and production
needs. To learn more, contact us today:
ca.vwr.com
l
1.800.932.5000
.
www.vwrsp.com/
antibodies
BD B
i
osc
i
ences
THE DELIVERY EXPERTS
CELL CuLTuRE MEDIA & SERuM
find Complete Product listings at
vwr.com
or Call
1.800.932.5000
|
50
find Complete Product listings at
vwr.com
or Call
1.800.932.5000
|
51
The
Vwr
®
Collection
High Quality. Superior Performance. Competitive Pricing.
The VWR Collection is an
exclusive line of products
that delivers the quality and
value you’ve come to trust
from VWR. Whether you
need equipment, instruments,
consumables, or chemicals,
there’s a VWR Collection
product for your lab...and your
budget. Learn more about the
VWR Collection by contacting
your VWR Sales Representative,
visiting
vwr.com
, or calling
1.800.932.5000
for more
information today!
look inside for:
VWR
®
symphony
™
Ultra-Low Temperature Freezers
(p. 54)
, VWR
®
Disposable Serological Pipets
(p. 29)
, VWR
®
Ultra High-Performance
Pipettors
(p.30),
VWR
®
symphony
™
4417/R Centrifuges
(p. 44)
1011 4m lit. no. 92893Cn.Ca
of Tissue Culture
EssEntials
Th
e
aTTn:
maIlroom:
If addressee is no
longer with the
organization, please
deliver to laboratory
products buyer.
Thank you.
Vwr lit library
c/o archway
2360 argentia rd.
mississauga on
l5n 5Z7
Forwarding Service Requested